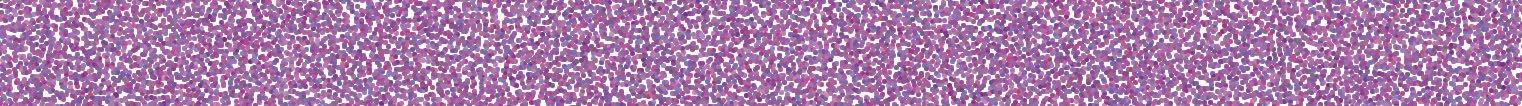

Readers shared views on Helene, UNCA’s urban forest, schools and more
Western North Carolina mayors look back at issues that defined 2025 —and what comes next
Do you remember what month the wildfires struck McDowell County? Or how about when the surprise hailstorm rained down on Asheville? Do you recall when the town of Marshall celebrated its post-Tropical Storm Helene reopening? Do you realize the number of times community members organized and demonstrated in the streets? In this week’s paper, join us as we revisit some of the key local events, initiatives, milestones and oddities that defined 2025.
Council holds its final
Wrapping up the year at Wedge at
46 WHAT’S NEW IN FOOD
Village Wayside to reopen in Grovewood Village, New Year’s Eve supper options and more
news tips
try our easy online calendar at MOUNTAINX.COM/EVENTS food news and ideas to FOOD@MOUNTAINX.COM
events/news to MXHEALTH@MOUNTAINX.COM
PUBLISHER & EDITOR: Jeff Fobes
ASSISTANT PUBLISHER: Susan Hutchinson
MANAGING EDITOR: Thomas Calder
EDITOR: Gina Smith
OPINION EDITOR: Tracy Rose
STAFF REPORTERS: Thomas Calder, Brionna Dallara, Justin McGuire, Brooke Randle, Gina Smith
COMMUNITY CALENDAR & CLUBLAND: Braulio Pescador-Martinez
CONTRIBUTING EDITORS: Jon Elliston, Mindi Meltz Friedwald, Peter Gregutt, Rob Mikulak
REGULAR CONTRIBUTORS: Emily Klinger Antolic, Christopher Arbor, Edwin Arnaudin, Danielle Arostegui, Mark Barrett, Eric Brown, Cayla Clark, Molly Devane, Ashley English, Merin McDivitt, Mindi Meltz Friedwald, Troy Jackson, Bill Kopp, Chloe Leiberman, Anabel Shenk, Jessica Wakeman, Jamie Zane
PHOTOGRAPHER: Caleb Johnson
ADVERTISING, ART & DESIGN MANAGER: Susan Hutchinson
LEAD DESIGNER: Scott Southwick
GRAPHIC DESIGNERS: Tina Gaafary, Caleb Johnson, Olivia Urban
MARKETING ASSOCIATES: Emily Baughman, Sara Brecht, Dave Gayler
INFORMATION TECHNOLOGIES: Jeff Fobes, Mark Murphy, Scott Southwick WEB: Brandon Tilley
BOOKKEEPER: Amie Fowler
OFFICE MANAGER: Mark Murphy FRONT




There are 17 Starbucks in the city of Asheville, but more other stores are selling intoxicating, psychoactive “hemp” products.
On Oct. 24, our state attorney general sent a letter to Congress calling for a ban of psychoactive intoxicating hemp tetrahydrocannabinol (THC) products derived from the cannabis plant because these products are threats to public health and safety.
As a result, Congress banned products containing hemp-derived THC. This is a historic win for public health and safety. The attorney general stated these are “Frankenstein THC products that get adults high and harm and even kill children.” In a year, producing and selling them will be a federal criminal act.
These products are created by manipulating hemp to produce forms of THC that can be more intoxicating and psychoactive than marijuana that is delta-9 THC. These forms of THC are then infused at high concentrations into a multitude of products that can intoxicate a person as severely as the most potent strains of marijuana. Some products are marketed as being far more potent than

delta-9 THC, and more potent products carry higher risk of harm.
These potent products are often packaged in ways to appeal to children. They are added in candy, chips, ice cream, vapes, cookies and other foods and chocolates or in drinks. They may be consumed accidentally by children.

The hemp-derived products may be created using harsh chemical solvents known to be hazardous to human health.
The use of THC is associated with acute psychiatric disorders, severe psychosis, addiction, injuries, poisonings, and lung, chest and heart disorders and drugged driving. See [avl.mx/f90] to download “Risks of Marijuana Use.”
All intoxicating psychoactive hemp THC products should be banned.
Civil lawsuits are in the works.
We have informed law enforcement.
— David G. Evans, Esq. North Carolinians Against Legalizing Marijuana Asheville
What began as a whisper to beautify our town square four years ago grew into a good-natured community expression and put Burnsville on Doug Tallamy’s Homegrown National Park website [avl.mx/d7j].
From the beginning of our Beautify Burnsville project, the town conveyed there was no budget for flowers in our town square. So rather than waiting on
rage-bait (n.) online content that is intentionally offensive or provocative
For our Year in Review Issue, we went with the Oxford Word of the Year. One of the many benefits of picking up your free copy of Xpress each week is the comfort in knowing we will not try and trigger you with rage-bait content. Here’s to hoping for a less enraging 2026. X
funds, community members donated plants from their personal gardens or purchased them at nearby nurseries and farmers markets. Other neighbors joined in broadcasting annual seeds, dropping off extra daylilies, irises and coneflowers, etc. Friends helped weed and water. A former mayor donated currency to purchase keystone plants from our local native nursery. Two generous neighbors donated hundreds of dollars for native plant plugs, which we ordered online and planted this spring. Nearly every plant came with a personal story and a wish to beautify a communal area. It was fun, apolitical and innovative.
As a result, the flowering garden was revered by countless people (elderly, children, artists, photographers, wedding parties and guests visiting from afar). In our fourth year, the garden was alive with a vast variety of beneficial insects, including luna moths and monarch butterflies. In addition, countless local honeybees swarmed to the native mountain mint for nectar.
Without our awareness on Tuesday, Sept. 16, three months ago, we arrived at town square to witness a group of hired workers pulling out the last of 100 flowering plants and throwing every plant in the back of a pickup truck. We stood in shock as a collective labor of love vanished. It was a violent, foolish scene that demonstrated a disconnect to nature, community and caring, and sent forth an unsympathetic message. Ironically, the exact opposite message of a serene, flowering garden.
If we had been kindly informed the flowering garden was no longer an asset to our town, by giving notice, we could have dug up 100 flowering plants and relocated them. Then, four years of a labor of love and togetherness would have ended nonviolently.
A senseless act which demonstrated misuse of power makes one wonder: “Why do people in office get to make decisions about public spaces when they don’t frequent them?” In four years of tending to the flowering garden, we never saw or heard from one county commissioner; no one said, “Stop planting.”
It’s a mystery what got in the way of being notified of plans to abolish the flowering garden. Or where the money came from to suddenly hire a landscaping company to replace the flourishing garden with plant species that diminish the ecosystem and aren’t native to Appalachia. Thus, efforts to restore biodiversity by building ecosystems that foster “life” also ended Sept. 16, 2025.
As a culture, we talk about securing a promising future for children while mindlessly destroying the fragile ecosystems (beneficial insects) needed to thrive. A flowering garden sustains more life than most people comprehend.
As 2025 comes to an end, let’s give the flowering garden closure by

remembering this project as a life-giving momentum and a model of perpetual optimism. The list of kind souls who participated enhanced the joyousness; thank you.
Going forward, instead of county commissioners deciding the fate of community space; wouldn’t it be nice if children decided what gets planted in a town square? Undoubtedly, the children wouldn’t vilify butterflies, bumblebees, caterpillars, hummingbirds or even a silly weed because children innately know these species bring joy, creativity, passion and dreaming. It is our sincere wish that one day, the children will reclaim nature’s treasures in town square.
We could not have foreseen such an unsparing ending and have been reminded: When they try to bury you, remind them we are seeds.
— Grace Collins Burnsville
Editor’s note: Xpress contacted the Yancey County manager and the members of the Yancey County Board of Commissioners with the letter writer’s points but received no response.
I am reaching out to share my connection to the Yancey County Town
Square garden, my gratitude and my grief over its traumatic loss.
I enjoyed the garden for four years and, for the past two years, supported the care of the Town Square garden weekly; it was a joy and educational. Grace Collins, who started the garden, planted and tended it, and educated herself over the years by taking classes and learning from other gardeners and lovers of flowers in the area. There were over 100 species planted. These native flowers came from many people and places, and planting happened weekly. There was a good, focused effort.
It was inspiring and heartfelt to watch the care and finesse Grace put into the planting and care. I witnessed from her what it meant to have passion for what you love. The flowers were located in the right spot for sun and water and their relationship to the other flowers. Weeding, organizing and cleaning were a routine part of the care.
Yancey’s Town Square was on the map as a pollinator garden. I counted over 300 pollinations by five species of insects on one mountain mint plant. It was a big highlight of my week.
As we cared for the garden, many would stop and share their own stories and ask questions. The Town Square garden was alive with children playing, groups meeting, artists painting, photos of the flowers, weddings and groups.
The Town Square was a colorful, happy place to meet and enjoy the day.
On the morning of Sept. 16, the beauty and joy brought to so many was destroyed without a warning and no opportunity to relocate over 100 plants. The Square garden was at the heights of its beauty. It felt to me like the destruction of the hurricane just one year before. So much needed joy was brought to our Yancey community through the joint effort that created this Square garden. I spoke to people from out of town who said they made a point to go to the Square garden on their way through.
I was heartbroken and in disbelief that those making the decision, which I understand to include the county commissioners, could be so disconnected from the people and what was enriching our town. The Square garden brought so much joy and learning. Like a good friend, always part of my life.
— GerAld FitzGibbon
Burnsville
Editor’s note: Xpress contacted the Yancey County manager and the members of the Yancey County Board of Commissioners with the points raised in this letter but received no response. X



What will we remember about our readers’ opinions in 2025? Judging from the year’s collection of letters to the editor and commentaries published in Xpress, their attention has been focused on a cluster of big issues — and a few outliers (we’re looking at you, pickleball!). Here’s a recap.
The year began barely three months after Tropical Storm Helene, and multiple readers weighed in on what should come next.
“I’m hoping that all building in and around rivers will not take place,” wrote Asheville reader Janice Doyle on Jan. 1. “To rebuild in the same place where destruction took place will be far from wise.”
Meanwhile, Weaverville reader Amy Longcrier, a water resources engineer, suggested on Jan. 15: “Provide more greenways and parks within the floodplain. Aside from natural areas, it’s the only responsible thing to do.”
And Asheville reader David Dixon offered on Jan 29: “Have we learned anything? Will the legislature and the municipalities tighten building codes, adjust zoning maps, pull development back from riverbanks, buy out structures and re-create wetlands, marshes and buffer zones? Don’t expect much.”
Readers also shared their personal takes on the disaster. “Being in a place that has experienced a disaster is not just witnessing destruction,” Asheville reader Marilyn Ball wrote on March 26. “It is witnessing the power of the human spirit to rebuild, reimagine and rise stronger than ever before. Thank you, Western North Carolina.”

Readers shared views on Helene, UNCA’s urban forest, schools and more

IN
HOT-BUTTON ISSUE: Drilling takes place on UNC Asheville’s forested property in this January shot taken from Anne Walch’s home. No other issue elicited the passion (and volume of letters) this year among Xpress readers than the university’s development plans for this urban forest. Photo courtesy of Walch
As the one-year anniversary of Helene approached, Swannanoa Valley retiree Bill Altork reflected: “For some of us, we will make visits to the gravesites of those who did not survive the disaster.
H ELPING P EOPLE. C HANGING L IVES.
Community Action Opportunities (CAO) will host a virtual public hearing on 12/18/2025 to discuss the Community Services Block Grant application submitted to the Office of Economic Opportunity on 12/05/2025 (CAO Board approved 12/02). CAO intends to use $899,300 for a self-sufficiency project serving a six-county service area.
To hear more about this program plan and to provide comment, please email Kate at kate.singogo@ar4ca.org for the hearing login info.
Some of us have moved away. For many of us, we have stayed and dug our feet back into the soil of our hometown, seeking to grow new roots and splice new beginnings onto the old ones.”
Wa
Greg Lowe, president and CEO of Mission Health and Mission Hospital, commented Oct. 1: “After the storm, Mission housed 700 patients, and over 1,200 colleagues slept on-site, ready to help. That devotion is more than professionalism — it’s love for community.”
The issue that sparked the most passionate reader reaction (and volume of letters) centered on UNC Asheville’s development plans for its 45-acre urban forest. The overwhelming majority opposed the development plans, which were revealed in June to be anchored by a soccer stadium.
In a January letter, Asheville reader Anne Walch wrote: “UNCA, align with your purported values. Please model intigritous stewardship of our ever-dwindling wild places. Once and for all, put this forest into conservatorship for generations to enjoy.”
But, Candler resident Richard Boyum wrote on April 9: “The intentions of the UNCA administration to utilize the resources of the urban forest to strengthen the university are based on both necessity and good intentions. They know what they are doing. They know why they are doing it. They should be trusted.”
Meanwhile, UNCA faculty members also weighed in, including Jonathan Horton on July 9: “As chair of the biology department at UNC Asheville, I am writing to express my strong opposition to the proposed development of a soccer stadium in one of the last remaining urban forests in Asheville. This proposal is deeply troubling — not only for its ecological consequences, but for the dishonest and opaque process surrounding it.”
Readers also expressed concerns about school funding. Wrote Asheville

Come enjoy a presentation about Givens Gerber Park: a more affordable rental retirement option (55+) and enjoy lunch on us.
Monthly fees are all-inclusive and based on income. RSVP required.
828.771.2938 | aadkison@givensgerberpark.org


resident Amanda Wilde on April 16: “Our community is already struggling after Hurricane Helene. Our kids have endured so much. Cutting school budgets only adds to the chaos. Our county commissioners went through the same disaster: How can taking away critical funding from our schools be the solution?”
Meanwhile, several parents voiced frustration with Buncombe County Schools’ policy for closing schools for weather reasons. “The merest appearance of the possibility of theoretical danger or liability does not justify Buncombe County’s kids missing hours of real instruction,” wrote Swannanoa reader Anthony Rodriguez on March 19. “It needs to radically change.”
GOODBYE, HELLO AND MORE
In January, remembrances poured in about longtime Xpress columnist Jerry Sternberg, who died Dec. 25, 2024. Offered Xpress Publisher Jeff Fobes: “Jerry, we’ll miss your spunk, the gleam in your trickster eyes, your big heart and your businessman’s acumen. Thanks for all you gave to Asheville.”
In August, two local writers on opposite ends of the political spectrum, Carl Mumpower and Bill Branyon,
launched a new column in Xpress, “I Beg to Differ.” “In these essays, Carl and I hope to exemplify how to have an enlightening — rather than an enraging — conversation between the left and right about local issues,” Branyon wrote. And Mumpower commented: “Without the ability to civilly discuss issues — be they political, social, emotional, economic or spiritual — we lose a crucial piece to our culture’s functional puzzle. Dogma is deadly.”
And a review of this year’s local opinions wouldn’t be complete without mentioning the flurry of responses to Weaverville’s pickleball controversy, including this Nov. 5 one from Weaverville reader Benjamin Gifford: “It is ridiculous to ask the town to shut down or move the courts after it spent so much money building them. Maybe the people so opposed should try out the sport and have fun with the rest of us.”
Whatever you think of pickleball — and however you have your fun — let’s try to carry that hopeful spirit into the new year.
— Tracy Rose X
A longer version of this piece will appear at mountainx.com.







Several years ago, I was diagnosed with cancer and underwent chemotherapy treatments. I’m now in remission and have felt blessed to be here except for so much pain. My feet and hands were constantly burning – a tingling sensation, almost like when your leg is falling asleep,” shares Barbara of Biltmore Forest. Barbara was suffering from Chemotherapy Induced Peripheral Neuropathy or CIPN. While chemo kills cancer cells, it also causes much bodily damage. Nerves, especially those far from the brain, are among the first to be harmed. 30-40% of cancer patients treated with chemotherapy experience peripheral neuropathy.
“Standing all day was not just a challenge, and it caused me physical agony. Keeping up with my busy schedule – forget about it. I couldn’t even go for walks in my neighborhood.” Barbara, like so many others, was prescribed Gabapentin help with the pain and told there was nothing anyone could do. In Doctors’ words, ‘there is no treatment for neuropathy.’
Then Barbara found Dr. Autum Kirgan, DACM, C.SMA, L.Ac of South Slope Acupuncture & Wellness. By blending the time–tested science of acupuncture with more modern medical technology, Dr. Kirgan has designed a natural solution for peripheral neuropathy.

“Acupuncture is incredible at restoring blood flow and stimulating damaged nerves, preventing them from dying off,” says Dr. Kirgan. “We take our treatments a step further by integrating FSM Therapy which targets specific nerves in the body using microcurrent. FSM Therapy is like watering a plant. This treatment will stimulate the blood vessels to grow back around the peripheral nerves and provide them with proper nutrients to heal and repair.
After only four weeks of treatment, Barbara is already seeing incredible improvement. “I’ve taken the handicap placard off my rearview mirror and I am finally back to walking my neighborhood. I can’t wait to see how

I feel at the end of my program! I used to think that this pain was just the price I had to pay for still being alive. Dr. Kirgan has really given me hope for a better life!”
The number of treatments needed to allow nerves to recover fully will vary from person to person and can only be estimated after a detailed neurological and vascular evaluation. If you or someone you love suffers from peripheral neuropathy (of any origin), call 828-575-5904 to schedule a consultation with Dr. Kirgan and her South Slope Acupuncture & Wellness team.
They are waiting for your call. New Patient

On Dec. 25, 2024, longtime Xpress columnist Jerry Sternberg passed away. Throughout much of January and February, friends, colleagues and readers submitted recollections of his contributions to the community.


Mary Katherine O’Donnell, pictured, and her husband, Patrick Hackney, of Woodfin, welcomed the first baby of 2025 at Mission Hospital. Frances Rosemary Hackney was born at 12:28 a.m., Jan. 1. Also featured in this photo is Frances’ big sister, Fern Margaret. X

One of the biggest stories at the start of the year involved the lawsuit and counterlawsuit between Orange Peel Events and Asheville Pizza and Brewing. The two businesses partnered in June 2019 when they purchased the property at 75 Coxe Ave., where they launched Rabbit Rabbit. Some of the lawsuits’ claims have been dismissed, but the case is ongoing. Asheville Pizza and Brewing rebranded Rabbit Rabbit as Asheville Yards. In October, Orange Peel announced plans to open a new outdoor venue on Thompson Street.





On Jan. 2, city-owned parking garages resumed charging visitors, after waiving all fees in the aftermath of Tropical Storm Helene. X





The N.C. Department of Health and Human Services increased the total death toll related to Tropical Storm Helene to 105.
Bird flu was discovered in a deceased waterfowl at Lake Julian Park on Jan. 31.






At a Jan. 7 press conference, officials — including Mayor Esther Manheimer and Gov. Josh Stein — reported that the City of Asheville would receive $225 million out of the $1.65 billion WNC received from the Community Development Block Grant. X


President Donald Trump arrived in WNC on Jan. 24 and met with residents impacted by Tropical Storm Helene. During his visit, he criticized FEMA’s response. That same day he signed an executive order establishing the Federal Emergency Management Agency Review Council, a 20-member committee assigned with conducting a “full-scale review” of the agency. X



Featuring such sharp bars as “If you die on the job, they goi’n clock you out first/And they won’t put a dime toward your funeral and hearse,” the title track from Asheville’s hiphop kings feels more relevant by the hour. Listen to the track at avl.mx/f8t. X
The first snow of the year arrived in WNC on Jan. 10. This snowman bummed a smoke (and lighter) in downtown Asheville shortly thereafter. X

“As a mother and a product of Buncombe County Schools, I have a hard time sitting here before my community, when I ran on strong communities, to take $4.7 million away from our students,” Commissioner Jennifer Horton stated at the Jan. 21 Buncombe County Board of Commissioners meeting. Horton and fellow Commissioner Martin Moore were the only two members to vote down the budget cut. X

Hundreds of acres burned in Old Fort on Jan. 29-30 as wildfires spread across McDowell County. X


“Provide more greenways and parks within the floodplain. Aside from natural areas, it’s the only responsible thing to do.”
— Amy Longcrier, water resources engineer, Weaverville, in a Jan. 15 letter to the editor. X
Asheville City Council approved, 5-1, a three-year contract with the Asheville Downtown Improvement District (ADID) — a group composed of Asheville Downtown Association, Asheville Chamber of Commerce and California-based consultants Nextstreet — as the service provider for the Business Improvement District (BID).
Opened:
- Hail Mary

Closed:

- ELDR
- Dilbar
- Bluebird Bubble Tea
- Bouchon (closed then reopened in late January as Creperie Bouchon)
Reopened after
Helene:
- Mean Pies (previously a food truck at pl b urban winery, reopened at OWL Bakery)

On Feb. 3, siblings Karen and Victor Perez, 15 and 18, respectively, organized the first of two February demonstrations against the Trump administration’s immigration policies and deportations. More than 100 demonstrators gathered in Pritchard Park. The group later made its way down Haywood Street to the Flint Street bridge over Interstate 240, ending the

“As the Sheriff, I am not in charge of operating the churches or schools within this community but I am elected to ensure the safety and security of ALL the residents in Buncombe County. WE are a community of WE and because I have deputies positioned in schools as School Resource Officers, my stance is clear and strong that immigration enforcement is not allowed on our school campuses unless forced through a valid court order.” — Quentin Miller, in a Feb. 7 statement responding to the Trump administration’s immigration policy X

FIVE HUNDRED AND COUNTING: According to a Feb. 19 article published by the Citizen Times: “Nearly five months after Helene, more than 500 Buncombe County households are still living in hotels through FEMA’s Transitional Sheltering Assistance program. The program provides temporary housing in hotels to survivors of natural disasters.”X

Asheville mourned the death of Brian Canipelli, chef and owner of Cucina 24, who died Feb. 6 at the too-young age of 46 while on the line at Cucina 24. He had been honored as a StarChefs Rising Star Chef in 2013 and was a 2016 semifinalist for the James Beard Foundation’s Best Chef: Southeast award. X
In a Feb. 6 email to students, UNC Asheville Chancellor Kimberly van Noort announced the university suspended all existing graduation requirements linked to diversity, equity and inclusion courses, per a Trump administration executive order. X



- La Bodega by Curate
- Rhubarb
Reopened after Helene:
- Wildwood Still
- Golden Hour
- Root Down (previously at Salvage Station, reopened at Terra Nova Beer Co. in Swannanoa)
Dozens of residents protested on the UNCA campus on Feb. 15 to advocate for the preservation of 45-acres of wooded property owned by the university. X


BillyStrings returned to Asheville for six sold-out shows at Harrah’s Cherokee Center –Asheville,Feb.6-8 and Feb. 14-16.










Asheville Art Museum’s new exhibit, “Asheville Strong: Celebrating Art and Community After Hurricane Helene,” launched Feb. 13, and ran until May 5.










On Feb. 20, 10 members from the Asheville Fire Department returned home from Kentucky, where they assisted with recovery and rescue efforts following a deadly flood.





the tech billionaire whom President entrusted to oversee the Department of Government Efficiency (DOGE), was front of mind for many residents who showed up to speak with members of U.S. Chuck Edwards’ staff at the Buncombe County Health and Human Services building on Feb. 25. Meanwhile, roughly 30 more constituents hoisted signs outside the building, expressing their frustration and anger over a number of issues. They objected to the control Musk was exhibiting over federal operations and the steep cuts he made to various departments and programs. X

Cartoon by Randy Molton

The Whitson Avenue Bridge reopened in Swannanoa on Feb. 26, five months after Tropical Storm Helene caused major damage to its infrastructure. “The bridge provides a vital connection between the north and south sides of the Swannanoa community,” Buncombe County posted on social media. “The reopening of the bridge offers a beacon of hope, and a symbol of progress for recovery efforts after the X


“Asheville City Council’s plan(s) for new housing are a mess. There is no guiding principle. It is made up as each new project/ idea comes before them to be voted on.” — John Appleby, in a letter to the editor published on Feb. 26. X
Is a song from 2017 supposed to make you cry eight years later? As part of The Resonance Sessions, the longtime local performed his ode to the Madison County seat in the freshly mucked out stairwell of the Old Marshall Jail, mere weeks after Tropical Storm Helene washed through. The results are timeless. Listen to the track at avl.mx/f8q. — Edwin Arnaudin X

Over 150 protesters assembled at Pack Square on March 2 to show their support for Ukraine, following the Feb. 28 fallout inside the Oval Office between President JD Vance



is a Highway

Over 200 demonstrators gathered outside the Federal Building in downtown Asheville on March 4 to show their support of federal employees, Medicaid, Supplemental Nutrition Assistance Program (SNAP), Social Security and Ukraine. Participants chanted, “This is what democracy looks like,” “Save our parks” and “People over profit.”

“Buncombe County needs to seriously reexamine its policies and procedures for ‘winter weather.’ I put that in quotation marks because every other Buncombe County Schools (BCS) parent I know knows that what qualifies as ‘winter weather’ in this county does not need to be particularly wintry and doesn’t even need to actually manifest as actual weather for there to be cancellations or delays.” — Anthony Rodriquez, Swannanoa, in a letter published March 19. X

TOWN HALL: U.S. Rep. Ferguson Auditorium at A-B Tech during his March 13 town hall. Along with the 350-plus people inside the event space, an estimated 2,500 constituents gathered outside. Residents voiced concerns over federal cuts, shared their support for Ukraine, criticized Elon Musk and the Department of Government Efficiency (DOGE), questioned trade wars with Canada and Mexico and implored Edwards to be a check on presidential power. X


Photo by Brionna Dallara
Hundreds gathered at Pack Square on March 8 for Asheville’s International Women’s Day march — speaking out for women’s rights, showing support for Ukraine and protesting the Trump administration. X

Democratic state legislators — Sen. Julie Mayfield (District 49) and Reps. Lindsey Prather (District 115), Brian Turner (District 116) and Eric Ager (District 114) — held a town hall March 20 at the Ferguson Auditorium at A-B Tech, the same location as U.S. Rep. Chuck Edwards’ March 13 gathering. The four elected officials addressed a number of issues, including the potential impact of federal cuts on the community as well as details about the Disaster Recovery Act of 2025 – Part 1. The act provides $524 million in total aid for WNC and marks the first bill Gov. Josh Stein signed into law on March 19. X
Starting March 23, multiple wildfires broke out in Western North Carolina. Over 6,500 acres burned in the course of three days. X
The Penrose, N.C.-based artist gutsily closes out Among Friends — his collection of covers of songwriters he admires and has befriended over the years — by “covering” his own tune about resilience and hard work. Three-anda-half rousing minutes later, it’s clear he belongs among the honored few. Listen to the track at avl.mx/f8p. — Edwin Arnaudin X

Reopened after Helene:
- Sovereign Remedies (under new ownership) - Dobra Tea downtown

SURVEY SAYS: Buncombe County announced April 1 that the Community Assessment for Public Health Emergency Response (CASPER), a door-to-door survey that Buncombe County Public Health planned to conduct the first week of April, had been canceled after the Trump administration fired 10,000 workers at the Department of Health and Human Services. X
U.S. Rep. Chuck Edwards released a 61-page account, Report to the President: What’s Needed to Advance Hurricane Recovery in Western North Carolina, on April 15. While critical of the Federal Emergency Management Agency (FEMA), the report warned against dismantling it. X
Thousands gathered at Pack Square Park as part of the April 5 Hands Off Nationwide Day of Action organized by Indivisible. The two-hour rally featured nearly a dozen speakers, addressing issues on health care, climate, veterans’ rights, Social Security, Medicaid, education and the impact of federal cuts on local organizations and institutions. Along with speakers, the gathering featured performances by Womansong of Asheville and the Asheville Gay Men’s Chorus. X




Swannanoa River Road reopened April 4, following six months of cleanup, restoration and construction by multiple agencies.













Ele Ellis became the new CEO and general manager of BlueRidgePublicRadioon April 1.



Asheville City Council approved, 7-0, an updated plan for how to spend $225 million in disaster recovery funds from the U.S. Department of Housing and Urban Development (HUD) at its April 8 meeting. The initial draft was rejected by HUD because it included diversity, equity and inclusion criteria. At the meeting, Rachel Cohen, a member of the Sunshine Movement, a local climate activist group, unscrolled 178 signatures of residents who want to build back greener as part of the $225 million disaster recovery funding plan. X





On April 8, the Asheville Tourists hosted the first home game of the season amid an 18-month, $38.5 million renovation to McCormick Field. X



Roughly 375 residents attended a drop-in meeting at the Renaissance Asheville Downtown Hotel April 24, where the N.C. Department of Transportation presented plans for the northern section of the Interstate 26 Connector project. The updated plans now include an overpass that will cross Patton Avenue, a change that has drawn criticism from hundreds of community members. X
APPROVED: North Carolina’s plan for spending $1.4 billion in federal disaster block grants was approved by the U.S. Department of Housing and Urban Development, according to an April 25 press release from Gov. Josh Stein’s office. X

Margaret Belk was selected as the 2025 Xpress Poetry Contest winner for her poem “The Collective.”

Best known as “MJ Lenderman’s drummer,” the Asheville-based artist released his own alt-country gem Losin’ earlier this year that’s full of contri- butions from his touring buddies and witty lyrics that confront death, forced removal from community and heartbreak — but also plenty of optimism, as evinced by this melancholic yet motivational tune. Listen to the track at avl.mx/f8r. — Edwin Arnaudin X
An April 30 press release from Conserving Carolina reported that 23 members of AmeriCorps Project Conserve who were serving full time at 14 nonprofits and local governments were terminated at the direction of the Department of Government Efficiency (DOGE). X




Several environmental leaders participated in a forum at The Mule at Devil’s Foot Beverage on April 9 to discuss environmental concerns based on Trump administration policies. The event, Support Our Public Lands, included short presentations by representatives of more than half a dozen organizations. Speakers expressed particular concern about the U.S. Department of Agriculture’s decision to roll back environmental protections around logging projects in more than half of U.S. national forests, including Pisgah and Nantahala. The administration’s plans to sell some public lands also raised alarms. X
- Zen Sushi’s second location at S&W Market
- Rowan Coffee’s second location and roastery on Haywood Road
Closed:
- Session at Citizen Vinyl - Creperie Bouchon
- Cultivated Cocktails downtown
- Flour Focaccia Sandwich Shop at S&W Market
Reopened after Helene:
- Baba Nahm (new location at 60 Biltmore Ave.)
- French Broad River Brewery
“We’ve already lost 40% of our trees in Buncombe County [from Tropical Storm Helene], which is exacerbating fire risk and landslide risk, and UNCA’s response is to cut down more trees? Let’s be very clear: UNCA’s designated property is part of the state school system and therefore state land, owned and maintained by our taxes.” — Jen Hyde, Asheville, in a letter published April 16. . X
- Summit Coffee RAD location (reopened as a coffee truck at RAD Brewing Co.)
- Salsa’s
- Café Bomba


Marshall Magic Days, a downtown fes- tival that organizers billed as an “open house,” showcased the town of Marshall’s recovery progress, May 1-4. X

A surprise hail storm briefly struck the region, pelting cars, homes and pedestrians alike on May 8. X


Around 300 residents gathered on May 1 at Pack Square Park for a May Day demonstration. “Current efforts by [President] Trump and billionaires threaten to reverse decades of social progress achieved through struggle,” stated a press release from the event’s organizers, WNC Workers Assembly and Asheville Food & Beverage United. “However, workers across the country are mobilizing to build a powerful movement to stop this billionaire agenda and create a more just world for all.” X


At the May 6 Buncombe County Board of Commissioners meeting, data revealed that 12,235 housing units were reported damaged by Tropical Storm Helene to FEMA — an increase of 100 from the previous month. X
On May 15, the U.S. Department of Housing and Urban Development approved the City of Asheville’s plan for $225 million in federal funding to aid in Tropical Storm Helene disaster recovery. X



THAT’S A WRAP: The post-Tropical Storm
Helene care site at Owen Pool in Swannanoa closed up shop in early May. It was one of eight sites that Buncombe County launched in the wake of the storm and the last site to close.





CHEERS: In early May, the Public Media Journalists Association named Laura Lee the 2025 Editor of the Year for her work with Blue Ridge Public Radio. Lee now serves as editorial director at NC Local.
courtesy of BPR


Oscar Wong, the founder of Highland Brewing Co., died on May 25. “Oscar was a brilliant engineer-turned-entrepreneur who always embodied generosity, humility, and above all else, connection,” the brewery wrote in a May 27 social media post. “Oscar had a gift for making people feel seen and valued and often Oscar reminded us that success is not just about achievement but about giving back.” X



On May 10, MountainTrue’s Hartwell Carson completed a 10-day journey up the French Broad River, assessing the state of the waterway post-Helene. While debris remained, Carson noted surprise at the overall healthy state of the river. X
The veteran singer-songwriter and guitarist’s 12th album, Why the Worry, was almost scrapped in the wake of Helene. But with a little help from his friends — including two-thirds of The Wood Brothers — tracks like this upbeat tale of escaping to higher elevations to find peace of mind weathered the storm. Listen to the track at avl.mx/f8o. — Edwin Arnaudin X
100 YEARS AND COUNTING: On May 30, the WNC Nature Center celebrated its centennial.



no-cuts school budgets.”
— Christina Mason Asheville, in a letter published May 14. X

Opened:
- Pho Real
- ButterPunk
- Short Sleeves Coffee (Swannanoa)
- Fitz and the Wolfe Closed:
- Rite Rite (Wall Street location)
- Highland Brewing at S&W Market
Reopened after Helene:
- DayTrip (new location at 174 Broadway St.)
- Grind AVL
- Red Stag Grill

to tell members of the Buncombe County Board of Commissioners to invest more in education than what the proposed 2025-26 budget called for. X

After much community debate, heated discussions and even acts of vandalism, Asheville’s first business improvement district — which imposes an additional property tax on downtown property owners to fund services that improve the look and feel of the district — had its official launch June 2. Now referred to as the Asheville Downtown Improvement District (ADID), the program is managed by the Asheville Downtown Association in partnership with the Asheville Area Chamber of Commerce, Nexstreet and a board of directors. X

On June 14, Ashleigh Shanti, chef and owner of Good Hot Fish restaurant, won a James Beard Media Award for her debut cookbook, Our South: Black Food Through My Lens. X


The City of Asheville hosted the first of several summertime “Foam Frenzy” parties for kids of all ages on June 8. The free event took place at Kenilworth Park. Additional happenings occurred throughout the summer at various locations. X

“Social media algorithms steer us to content that fuels outrage and clicks on both sides of the political spectrum. Broadcast news often prioritizes sensational stories and images over a balanced view of an issue. One platform that gives context and measured analysis to the daily news is NPR and the “PBS News Hour,” programming that Trump wants to defund.” — John Owens, Hendersonville, in a letter published June 4. X

On June 3, Timothy Lloyd, president of the Asheville City Association of Educators (ACAE), led hundreds of boisterous public education advocates through downtown Asheville and around the Buncombe County administration building, asking the Buncombe County Board of Commissioners to increase the proposed funding for public schools for fiscal year 2025-26. During their 5 p.m. meeting, commissioners approved $121.8 million in education funding for Asheville City and Buncombe County school systems and A-B Tech. The ACAE had advocated for a combined $126.3 million for the two school systems. X


In response to the arrival of ICE agents in Los Angeles, Union of Southern Service Workers (USSW) organized rallies across the nation on June 9. In a press release, USSW stated its goals “are to free longtime labor and civil rights leaders David from federal detention and an end to the Trump administration’s escalatory actions on American communities, including by standing down the California National Guard and ending the brutal ICE raids that are terrorizing immigrant workers and their communities.” In Asheville, amid heavy rains, community members gathered at Pack Square as part of the nationwide X




Chimney Rock State Park reopens:


The N.C. Department of Natural and Cultural Resources and the N.C. State Parks celebrated the reopening of Chimney Rock State Park on June 27 — nine months after Tropical Storm Helene ravaged Western North Carolina. Gov. Josh Stein attended the event, where he also signed into law a $500 million Tropical Storm Helene recovery package.






Thousands of residents marched in downtown Asheville on June 14 as part of an all-day, multievent protest against the Trump administration. The day began with the nationwide No Kings Rally at Martin Luther King Jr. Park, followed by the No Clowns, No Kings event at Pack Square Park. An additional demonstration was held at Pritchard Park later that evening. X































Halfway through the group’s sonically rich LP Big Wheels, the frontman pays homage to his birth state with this rollicking ode to Southern hospitality, young love and natural wonders. If you find yourself booking a trip to Birmingham over the next year, tell ’em Doss sent you. Listen to the track at avl.mx/f8u. — Edwin Arnaudin X



















Asheville Forager
The Refinery at The Foundry Hotel
Foothills Watershed (Old Fort)
Xpress won several N.C. Press Association awards. This year’s contest was judged by members of the Nebraska Press Association. Former reporter Greg Parlier, right, earned second place in the News Feature Writing Editorial category for his article, “Marshall Cleans Up After Helene Against All Odds.” Additionally, reporter Justin McGuire middle, took home third place in the Sports Feature Writing Editorial category for his story, “Basketball Star Henry Logan Broke Barriers, Conquered Demons in Legendary Life.” Managing editor Thomas Calder, left, earned second place in the Arts and Entertainment Reporting category for his literary feature, “Taylor Brown’s Latest Historical Novel Explores 1921 Trench Warfare on American Soil.” And reporter Brooke Randle, not pictured, won third place for General News Reporting for her article, “Police Officers Struggle to Afford Asheville Addresses.” X
Photo by Jeffrey DeCristofaro



Members of The Resonance Sessions


“From voter suppression bills like the SAVE Act to the criminalization of protest, the Trump administration is launching a full-scale attack on our civil and human rights,” Indivisible Asheville/WNC, which sponsored the event with the N.C. Poor People’s Campaign, stated in a press release.
“But we know the truth: In America, the power lies with the people, and we’re rising to prove it.” X

— a collection of songs recorded in the Old Marshall Jail’s stairwell in October 2024 to benefit artists impacted by Tropical Storm Helene — hosted a release party for the album’s vinyl edition on Saturday, July 5, at Zadie’s Market patio in downtown Marshall.

A July 7 fire at Goodwill Industries’ West Asheville complex reignited long-standing Malvern Hills neighborhood frustrations over safety and neglect at the site. While no one was injured, residents filed complaints demanding stricter code enforcement and accountability, as Goodwill officials said they were working to address concerns. X
BACK IN TOWN: Gov. Josh Stein kicked off a weeklong visit to WNC on July 14 with a visit to the new terminal at Asheville Regional Airport.
A few hundred people gathered at Pack Square Park on July 17 as part of a nationwide series of “Good Trouble Lives On” demonstrations. The national day of nonviolent action, which marked the fifth anniversary of the death of congressman and Civil Rights icon John Lewis, was designed to defend democracy and carry forward Lewis’s legacy, organizers said.

On July 24, UNC Board of Governors approved next steps for a multimillion-dollar proposal “which would build a 5,000-seat soccer stadium, market-rate apartments and retail on UNC Asheville’s campus,” Citizen Times reported. “The project continued to move forward despite community opposition.” X

On July 18, Henderson County, the City of Hendersonville and local partners celebrated the grand opening of the first 6-mile stretch of the long-awaited Ecusta Trail, running from downtown Hendersonville to the Horse Shoe community. The remaining 13.4 miles of the trail, which will extend to Brevard in Transylvania County, are scheduled to be completed by the end of 2027.







In response to deadly flooding in Texas, several local organizations — including BeLoved, Mountain Core Mission and Asheville Independent Restaurant Association — raised funds and sent supplies to those in need.
On July 24, in the wake of increased gun violence in Asheville, Mayor Esther Manheimer and Asheville Police Chief Mike Lamb put out a joint statement. In it they declared: “As members of the community, we call on all of Asheville to work together to stop gun violence before it happens. Addressing it requires more than the dedication of our police department; it requires the active collaboration of city leaders, community members, and organizations working together to find solutions. By community members sharing information and cooperating with police, we can prevent retaliation, solve crimes more quickly, and create safer neighborhoods for everyone.” X

The most instantly catchy track from the indie-rock star’s latest album, Precipice, finds her confronting a familiar topic — toxic relationships — in a bold new way with help from producer Elliott Kozel. She may now call Los Angeles home, but she’ll always be part of the Asheville scene. Listen to the track at avl.mx/f8v. — Edwin Arnaudin X

“Plans are in the process of being approved for the new Ingles Swannanoa Valley shopping center,” wrote Pat Jackson, Ingles’ chief financial officer, in an email to Xpress on July 21. “The project will include demolition of existing shops, raising the site elevation and construction of Ingles’ newest prototype grocery store. In addition, there will be new, expanded small and large tenant space opportunities. ... We intend to get started as soon as we get final approval from the county.” The original store was closed in the aftermath of Tropical Storm Helene. X
“There’s little likelihood that [UNCA’s proposed] development will bring additional money to Asheville or Buncombe County. Stadiums are proven money-losing ventures, and dollars that residents spend there would simply be dollars they don’t spend at other local venues.” — Alli Marshall, Asheville, in a letter published July 30, in response to UNCA’s plan to raze 45 acres of forest. X



Photo by Caleb Johnson
On Aug. 10, thousands gathered at Harrah’s Cherokee Center – Asheville to hear U.S. Sen. Bernie Sanders speak. The event was part of his “Fighting Oligarchy” tour. Guest speakers included Patrick Baron , an assistant professor in the Health Sciences Department at Western Carolina University; Hannah Drummond , the chief nurse representative of National Nurses United at Mission Hospital; and the Rev. William Barber X

UNC Asheville announced it had paused negotiations on its plan to build a 5,000-seat soccer stadium Aug. 14. The decision came after extensive, monthslong pushback from community members, who opposed the plan’s call to demolish the campus’s 45-acre urban forest. X



Asheville City Council passed, 6-1, an expansion of the city’s panhandling ordinance. Council member Kim Roney was the lone dissenter in the Aug. 26 vote. During the same meeting, Council approved the controversial resolution to establish four Helene recovery boards. The measure shifts the existing 15 citizen advisory boards to meet on an as-needed basis.

“If all the advisory committees ‘need’ from the City of Asheville is ‘assistance,’ then I’m sure the city won’t mind if the committees continue their usual responsibilities sans this ‘assistance.’ No further suspension required.” — Janine Paris, Asheville, in a letter published Aug. 6, in response to the city’s ongoing conversation about the future of its 15 citizen advisory boards. X


Demolition of Lake Lure’s historic Flowering Bridge began on Aug. 18 after engineers deemed the century-old structure — severely damaged by Tropical Storm Helene — beyond repair. Originally built in 1925 and transformed into a beloved pedestrian garden in 2013 that attracted up to 200,000 visitors a year, volunteers are now restoring its gardens while officials have long-term hopes to build a new bridge to reconnect Lake Lure and Chimney Rock. X
Backed by head-nodding, country-laced production that’s true to his roots, this mainstay of the local hip-hop scene delivers a passionate ode to the community that’s held him down since day one and doubles down on his commitment to the place he calls home. Just as Petey Pablo got North Carolina to raise up 20-plus years ago, this MC is all but guaranteed to get your hands up. Listen to the track at avl.mx/f8w. — Edwin Arnaudin X
- Bru
Local combat veteran Jay Carey was arrested in Washington on Aug. 25 when he lit an American flag on fire outside the White House. Carey, a former congressional candi- date, set the flame in response to President Donald Trump’s executive order calling for penalties against flag burning. Carey arrived in Washington that same day as a mem- ber of Remember Your Oath, an protestingorganization Trump’s deployment of U.S. troops in the nation’s capital. The case is ongoing.X


Asheville Mayor Esther Manheimer , right, announced her decision to seek a fourth consecutive term in an Aug. 20 press release.
Asheville City Council member Kim Roney , left, announced her latest run for mayor shortly thereafter, on Sept. 1. The primary election will be held on March 3.

- Root Down at Terra Nova Brewing on the South Slope
Reopened after Helene:
- Corner Kitchen
- Zillicoah Beer Co.
- Udon Sushi & Noodle

After a successful inaugural edition last year, the Boomtown Arts & Heritage FestAVL returned to Pack Square Park Aug. 29-31, for more musical performances and activities. The brainchild of Asheville native Andrew Ellington, Boomtown featured notable local acts such as Papadosio, Toubab Krewe, Caitlin Krisko and The Broadcast, Empire Strikes Brass and the Asheville Symphony. X
ART PROJECT: The City of Asheville announced in an Aug. 28 press release that it will pursue plans for a new large-scale downtown arts and entertainment center in partnership with ATG Entertainment, a private, United Kingdom-based company. For years, the city has considered updating the Thomas Wolfe Auditorium, but the projected cost of the needed renovations is prohibitively high. The proposed 2,500-seat facility would be designed to accommodate concerts, community events and traveling Broadway productions, which are beyond the Thomas Wolfe Auditorium’s capacity. X

Several hundred residents convened at Pack Square Park on Labor Day as part of the “Workers Over Billionaires” rally. The event was part of a nationwide protest against President Donald Trump and his administration. The local event included a march through downtown. X


Buncombe County held its 86th — and final — community briefing on Sept. 3, nearly a year after Tropical Storm Helene hit. X
An estimated 250 residents lined portions of Weaver Boulevard and Broadway in North Asheville for the Sept. 6 Wrap the Woods pop-up art installation. The event was planned prior to UNCA’s Aug. 14 announcement that it would pause its plans to develop the 45-acre wooded lot. X




On Sept. 4, President Donald Trump’s Department of Justice notified Buncombe County and the City of Asheville that it would “investigate and enforce violations of federal civil rights laws to the fullest extent possible,” if either municipality adopted any of the 39 recommendations from the Community Reparations Commission’s final report.


The National Park Service announced the completion of two landslide repair projects located at mileposts 375 and 380 and reopened a section of the Blue Ridge Parkway from milepost 382, in Asheville, to milepost 355.3 at the Ridge Junction Overlook, near N.C. 80 and the entrance to Mount Mitchell State Park. X



Gov. Josh Stein traveled to the region to commemorate the one-year anniversary of Tropical Storm Helene and pay tribute to the lives lost.
and
X
Josh Copus , second from left, owner of Zadie’s at the Old Marshall Jail, unveiled his latest project, Building Community Brick Project, which invites residents to inscribe reflections of Tropical Storm Helene on clay bricks. The ultimate plan, he noted during the Sept. 27 event, is to build a

Opened:
- Periscope Bar at S&W Market
- The Crowbar
- Jazmin
- Finest
- Piccolina Closed:
- Another Broken Egg
Reopened after Helene:
- Zella’s Deli (new location on Tunnel Road)
- Tiger Bay Café (new location inside Ben’s Tuneup)

Cartoon by Randy Molton
Tracked at West Asheville’s Drop of Sun Studios, the alt-country favorites’ new album, Bleeds, showcases the band’s ever-growing sound and noticeably confident vocals from frontwoman Karly Hartzman, whose portraits of quirky Southern life and love on the collection’s lead single conjure some of her most vivid imagery yet. Listen to the track at avl.mx/f8x. — Edwin Arnaudin X
Events throughout the month honored the one-year anniversary of Tropical Storm Helene, offering residents opportunities to reflect on all that transpired over the previous 12 months, as well as mourn the lives lost in the storm. Mountain Xpress participated in the Sept. 24 The Heart of the Mountains event, organized by NC Local and hosted at UNCA’s Highsmith Student Union. X
Thousands gathered for the annual Blue Ridge Pride parade on Sept. 27. This year’s event centered on the theme of resistance and resilience and was twofold — a celebration of Pride and commemoration of Tropical Storm Helene. X


“We need a new performing arts center to replace our 85-year-old facility. I am happy to pay higher taxes to support this effort.”
— Bonnie E. Jones, Asheville, in a Sept. 10 letter to the editor, responding to news of the City of Asheville’s plans to work with a private company to begin building a new performing arts center. X
Residents gathered outside The Odd in West Asheville with sledgehammers and bats, venting their frustrations on an old piano as a way to raise money for community members displaced during Tropical Storm Helene. The Oct. 5 event was hosted by the small business Move It or Lose It. According to a press release, “The fundraiser brought in over $1,000 to relieve moving debts, diverted thousands of pounds of usable materials from the landfill, and brought joy and stress relief to dozens of ‘smashers.’” X

The U.S. Centers for Medicare & Medicaid Services (CMS) placed Asheville’s Mission Hospital in immediate jeopardy, the third time since 2019 that the hospital had faced the harshest sanction that can be levied against a health care facility, according to an Oct. 21 Asheville Watchdog article. X


At its Oct. 1 meeting, the Buncombe County Tourism Development Authority’s (TDA) board approved more than $9 million in new grants for projects aimed at attracting tournaments, athletes and families to the county for sporting events like cycling, soccer, baseball, diving and tennis. Earlier in the year, the board had awarded $2.15 million for restoration of Azalea Park’s John B. Lewis Soccer Complex, which was devastated by Tropical Storm Helene, and about $500,000 for parking improvements to Bob Lewis Ballpark in Candler. That brought the total of Tourism Product Development Fund grants for sports this year to more than $11 million. X
FUN: Richmond
Hill Park partially reopened on Oct. 11, after being closed due to heavy storm damage from Helene. X
“There’s a [cannabis] growing operation in Western North Carolina that is part of tribal lands. The problem is that I can’t find any legal way to get this pot … to the dispensary, which is in another noncontiguous part of the boundary,” Sen. Thom Tillis said during an Oct. 7 oversight hearing on the Department of Justice. Attorney General Pam Bondi stated that her staff would look into it. According to reporting from Asheville Citizen Times, Principal Chief Michell Hicks rejected allegations that the program went against federal law. X
RIP ANDREA CLARK: Photographer and community historian Andrea Clark, who spent decades working to ensure Asheville’s Black history would not be forgotten, died on Oct. 29. “Her photos captured everyday people, community gatherings, storefronts and the beauty of a neighborhood that was later devastated by urban renewal,” local writer and speaker Aisha Adams wrote in a Facebook post honoring Clark’s legacy. “Her archive is one of the few remaining records of a Black community that once thrived here.” X
T A K E IT TO THE ( R I V E R)



for the Oct. 18 No Kings rally. The event featured multiple speakers, musical performances and a march through downtown. “There are some of those who call this gathering anti-American,” said speaker Molly Zenker, a registered nurse and Mission Nurses United representative. “But I think this may be about the most American thing I’ve ever done in my life.” X


Buncombe County held an Oct. 30 press conference to address the pause of federal Supplemental Nutrition Assistance Program (SNAP) payments due to the federal government shutdown. Local representatives were joined by members of the nonprofits MANNA FoodBank and Bounty & Soul. According to the N.C. Department of Health & Human Services, 29,551 individuals representing more than 16,000 Buncombe County households rely on SNAP to buy food. After North Carolina joined 24 other states in a lawsuit against the U.S. Department of Agriculture to address the withholding of the critical funding, the government agreed to tap $4.65 billion in contingency funds. X
The N.C. Arboretum hosted its third annual “The Wizard of Paws,” a Halloween dog parade, on Oct. 26. X

“I am all for AdventHealth giving Mission a run for their money. Considering how generally unhappy the community is with Mission, I think some competition is well warranted.”

— Joan Signorille, Asheville, in an Oct. 22 letter to the editor. X
- Easy Tiger
- Imperial Street Food
- Posana’s second location in South Asheville
- Jersey South Bagel Co.
- Papa Dunk’s Family Kitchen
- Mountain Madre’s second location on Merrimon Avenue
- La Pizza Party
Closed:
- Taco Boy (West Asheville location) Reopened after Helene:
- French Broad River Pizza
- Wedge Foundation
The native singer-songwriter and guitarist got through Helene with help from his North Asheville community — experiences that inspired him to write this ode to kindness as those around him valiantly pulled together. Over a year after the natural disaster, the tune feels more inspirational than ever. Listen to the track at avl.mx/f8s. — Edwin Arnaudin X



Voters in Woodfin and Weaverville cast their ballots in the Nov. 4 municipal election. In Weaverville, Dee Lawrence was elected as the town’s next mayor. He is joined by three new Town Council members: Jennifer Young, Phil Barnett and Mark Endries. In Woodfin, residents reinstated Philip Cohen to the Town Council, as well as newcomers Chip Parton III and Dan Bowers. Meanwhile, Larry Hopkins and Gordon Maybury were reinstated as trustees to the Woodfin Water and Sewer District. Carter James won the third open seat. X














Local blues musician and Emmy-nominated chanteuse Kat Williams died on Nov. 12. She was 58. X







“The Multimodal Transportation Commission urged Asheville City Council to ‘lean toward ridership,’ and their vote clearly favored a more frequent, effective system. Frequency is freedom — the freedom to trust transit, to skip the schedule, to build a life around reliable mobility. Asheville should choose real freedom for the many, not symbolic service for the few.” — Vaidila Satvika, Asheville, in a Nov. 26 letter to the editor. X
















The 43-day federal government shutdown ended on Nov. 12. During the shutdown, North Carolina joined 24 other states in a lawsuit against the U.S. Department of Agriculture to address the withholding of the critical funding for the Supplemental Nutrition Assistance Program (SNAP), which helps low-income residents buy food. In Buncombe County, more than 16,000 households rely on SNAP. New legislation signed by President Donald Trump to end the shutdown also included language that removes what lawmakers called “a loophole” from the 2018 farm bill that allows products such as delta-8, delta-9 and THCA to be sold legally. The law is set to go into effect in November 2026 and would effectively spell the end of the hemp industry nationally. X




Gov. Josh Stein presented six North Carolina Awards and recognized eight Helene Heroes at the 2025 North Carolina Awards, hosted at the Omni Grove Park Inn. Recipients of the Helene Heroes included: Clair Neal, CEO of MANNA FoodBank; Matt Martinka and Nathan Curlee of Duke Energy; Amanda Watts, who helped establish a Burnsville field hospital; Pastor David Lewkowicz and DeLaina Lewkowicz of The Bridge Church; and


by Thomas Calder


Asheville Yards launched its Holiday Ice Rink & Winter Wonderland, Nov. 26. The rink remains open through Monday, Jan. 19. X
Demonstrators marched in downtown Asheville on Nov. 16 in protest of U.S. Customs and Border Protection’s (CBP) operation in Charlotte, Blue Ridge Public Radio reported. The demonstration, held by the Party for Socialism and Liberation in Western North Carolina, was organized a day after Asheville Mayor Esther Manheimer said the city may be a target for CBP. X
SIGNING OFF: Asheville
Police Chief Mike Lamb retired on Nov. 21. X


This local siren can do pretty much anything, and while her rip-roaring numbers are a thrill to experience, slower-tempo ballads like this standout from the rocker’s latest EP, Everything I Need, show off her vocal prowess — and the wide-ranging talents of her bandmates — in exciting ways. Listen to the track at avl.mx/f8y. — Edwin Arnaudin X




by

Several holiday parades took place throughout Buncombe County, including the Town of Weaverville’s annual gathering on Dec. 7. The event featured dozens of local businesses and organizations, including the North Buncombe High School marching band. X




















Black Mountain announced on Dec. 10 that Town Manager Josh Harrold submitted his resignation. His last day will be Monday, Jan. 26. “During his seven-year tenure, Harrold led the town through a period of substantial growth and challenges, including the COVID19 pandemic and Tropical Storm Helene,” the press release read.

“The Town Council will begin the process of identifying an interim town manager and initiating a formal search for Harrold’s successor.”


“I appreciate that the Mountain Xpress is trying to promote improved tolerance between both sides of the political fence, and less identity politics, by running the contrasting columns of right-representing Carl Mumpower and left-representing Bill Branyon.” — Margaret Rockwood, Dublin, Ohio, in a Dec. 3 letter to the editor. X








Mission Hospital was veri- fied by the American College of Surgeons (ACS) as a Level 1 trauma center on Dec. 4. This is the highest recogni- tion for trauma services in the United States. Mission is the only ACS-verified Level 1 trauma center in WNC.




On Dec. 5, the City of Asheville announced the appointment of DK Wesley as the new city manager. She replaced outgoing City Manager Debra Campbell. Assistant City Manager Ben Woody will serve as interim city manager until Monday, Jan. 12.




According to a press release from the city, Wesley “is a seasoned local government executive with over 25 years of progressive leadership in city and county management.”

Federal EmergencyManagement Agency (FEMA) announced on Dec. 5 that the latest round of federal funding — $29 million — was on its way to Western North Carolina to reimburse cities, towns and state agencies for Tropical Storm Helene recovery projects.



The same release notes that Wesley has served as an assistant county manager with Buncombe County for more than six years. X



Opened:
- Hotel Eve - Lucky’s (inside The Odd)


- Chorizo (reopened in Grove Arcade after closing in 2016)
- Rite Rite (Weaverville Road)
- Terra Nova Beer Co. (both locations closing end of 2025)
Reopened after Helene:
- Okie Dokie’s Smokehouse (Swannanoa)
Datrian Johnson, “O Come, O Come, Emmanuel”
Asheville is home to what could be the best vocalist in the country. Anchoring the local holiday benefit album, Winter’s Grace, the singer figuratively — and possibly literally — takes listeners to church with a mighty rendition of the Christmas classic that’s sure to stay in seasonal rotation for decades to come. Listen to the track at avl.mx/f8z. — Edwin Arnaudin X
Western North Carolina mayors look back at issues that defined 2025 — and what
BY JUSTIN M c GUIRE
jmcguire@mountainx.com
Towns across Western North Carolina continued to deal with the aftermath of Tropical Storm Helene in 2025, but the year was about more than that.
tinued the engineering and design of the Ecusta Trail linking Brevard and Hendersonville and broke ground on the first multiunit affordable apartment development in 13 years.”
— Maureen Copelof, Brevard mayor


In Fletcher, officials launched a new farmers market. Brevard broke ground on an affordable apartment complex and continued work on wastewater treatment upgrades. In Canton, town leaders focused on attracting young families and developing economic opportunities while navigating the 2023 closure of the the Pactiv Evergreen paper mill.
For this month’s Around the Region, we asked WNC mayors to discuss Helene recovery and other issues that shaped 2025. They also look ahead to 2026.
Aside from Helene recovery, what was the most significant development in your town?
“We were proud to start Fletcher Community Farmers Market, which was able to support the local farmers and give residents a space to get affordable fresh foods and produce.”
— Preston Blakely, Fletcher mayor
“We moved forward with several transformational projects that will positively impact our community for decades. We began the upgrade and expansion of our wastewater treatment plant to better support residential and commercial development, con-
“The most significant development was Canton’s conscious decision to boldly move forward. We know there’s still a long road ahead, especially securing the support we need from Washington and the closure of the mill, but we’re no longer standing still in purgatory. Canton is choosing to focus on attracting young families, expanding economic opportunities and building the ‘hometown of tomorrow,’ which creates a sense of home but embraces new ideas and technologies.”
— Zeb Smathers, Canton mayor
Who had the biggest impact on your community?
“Our nonprofit community and the hundreds of volunteers and supporters who stepped up whenever needed. 2025 saw the need for continuing services due to the trauma and devastation of Helene, followed by extensive forest fires that threatened our community. Both disasters impacted our community physically, emotionally and economically. Different nonprofit organizations were there to meet the unique needs of our community each and every time they were called upon.”
— Copelof



LOOKING BACK: Western North Carolina mayors reflected on 2025 and looked ahead to 2026. Pictured, from left, are Brevard Mayor Maureen Copelof, Canton Mayor Zeb Smathers and Fletcher Mayor Preston Blakely. Photos courtesy of the mayors
“The everyday citizen. Not a government agency or organization, but the people who faced floods, recovery challenges, rising costs and the uncertainty of these times, yet still got up each day, went to work, raised their children and kept believing better days are ahead. They are my heroes. Their grit sets the standard for all of us in elected office,
reminding us who we serve and what resiliency looks like.”
— Smathers
“Volunteers, frontline workers and our staff members and council who stepped up repeatedly during Helene
CONTINUES ON PAGE 32



and thereafter. Town staff’s commitment kept our community going and our services delivered at a high level. Our public works, police and parks and recreation departments helped to make sure our families and communities remain connected.”
— Blakely
What long-term challenges from Helene will demand attention in 2026?
“Navigating the slow, excuse-filled and broken federal system that’s delaying the delivery of designated recovery funds to the people and communities who need them most. I’ve said it time and again: If you give WNC the resources and respect we’ve been promised, we will rebuild. But these delays carry real consequences, especially for families deciding whether they can continue calling WNC home.”
— Smathers
“Multiple local governments are seeing gaps in budgets that could have a real impact on services. We have a duty to rebuild responsibly and with resilience. The infrastructure that is built must be strengthened, and we need support from the state and federal governments to rebuild as funding is needed.”
— Blakely
“Ongoing challenges include: resolving funding issues with FEMA (Federal Emergency Management Agency) for critical city infrastructure (road) repairs; addressing the regional communication failures that impacted internal and external communication abilities; building resilience and redundancy into key municipal infrastructure systems; helping our community develop individual emergency plans; building community emotional/psychological resilience; and supporting residents and our nonprofit community as they continue to repair/ rebuild housing lost to Helene.”
— Copelof
“Early childhood education, affordable housing and growth. We see increased demand for different models of transportation, so we are seeing a demand to increase sidewalks, greenways and other transportation methods in that realm. These concerns shape daily life and remain central to how Fletcher grows in a balanced, community-centered way.”
— Blakely
“Challenges include: increasing the number of affordable housing units so that people across the economic spectrum can make Brevard their home; supporting our local small-business community during difficult economic times; attracting new economic growth that brings skilled, high-paying jobs that will allow our youth to remain here; balancing preservation with growth to protect the unique small-town charm of Brevard.”
— Copelof
“Affordability. Nothing is changing the DNA of WNC more than that challenge. Even as we work to bring new economic opportunities to Canton, every plan comes with a central question: How do we ensure the people who’ve called this place home for generations can still afford to stay? Diagnosing the problem is easy; solving it is harder. It will take time, discipline and smart decisions.”
— Smathers
“I am optimistic about continuing to extend our community’s trail network, which includes building new trails at Bracken Mountain Preserve, extending the Estatoe Trail from the Mary C. Jenkins Community Center to Rosman Highway and continuing to develop the Ecusta Trail. Building out this green network connects people and places, allows alternate transportation methods to become a reality, increases healthy outdoor activity, promotes economic development and improves the overall quality of life for our community.”
— Copelof
“We expect meaningful progress on the redevelopment of the mill site and long-planned flood recovery projects to be completed. Second, we’re reaching a point where we can bring our citizens back into the process and truly ask what they want to see for Canton’s future. After being in crisis mode for so long, it feels like we’ve finally turned the corner toward rebuilding with our community, not just for it.”
— Smathers
“I am optimistic about the continued work on our town center project to create a central downtown for Fletcher. We are working diligently to develop the property surrounding Town Hall to create a mixed-use development that our residents want. Additionally, we have received grants to expand our Cane Creek Greenway and preliminary work is in the works and we are excited about the pending expansion.”
— Blakely X

Asheville City Council’s Dec. 9 meeting had no presentations or public hearings.
Council approved several resolutions authorizing the city manager to do the following:
• Amend a contract with Southern Disaster Recovery to “include all prior spending and future spending under said contract for the purpose of Tropical Storm Helene-related debris removal recovery efforts,”
according to the agenda. The $26 million budget amendment will be reimbursed through the Federal Emergency Management Agency (FEMA) Public Assistance Program as well as state funding.
• Execute a contract with CDR Maguire to monitor Tropical Storm Helene-related debris removal. The $4 million budget amendment will be reimbursed with FEMA Public Assistance as well as state funding.
• Apply to the French Broad River Metropolitan Planning Organization for a fiscal year 2027 Unified Planning Work Program grant for a planning study for the Hilliard Avenue corridor.
• Amend a general services contract with Benevate LLC, dba Neighborly Software to include funding and modules for Community Development Block Grant - Disaster Recovery grant management.

• Execute a contract with JR Merrimon & Co. to perform service line inventory in Shiloh for the Water Resources Department.
• Execute an easement agreement with Emerson Ridge Subdivision Homeowners’ Association, Inc. for property on Spivey Mountain Road.
• Accept donations from the Asheville Police Foundation of a pickup truck, a trailer and an all-terrain vehicle for the Asheville Police Department.
• Council voted, 5-2, to appoint Jonathan Anzollitto to the Planning and Zoning Commission. Anzollitto is an analyst with Urban3, a local urban planning firm.
• Council removed an item on the consent agenda to provide a new resource center location for the Asheville Police Department at the Tanger Outlet Shopping Center. The issue will be revisited in January. This story was supported by the Fund for Investigative Reporting and Editing. — Jessica Wakeman X



BY MARK BARRETT
The main duties of county registers of deeds in North Carolina are to operate repositories of real estate records and birth and death certificates.
Nowhere in state law are they charged with organizing volunteers to locate and bring supplies to people left incommunicado by a natural disaster or to flush toilets during a water outage.
Taking on those duties in the days after Tropical Storm Helene ripped through Western North Carolina is what earned Buncombe County Register of Deeds Drew Reisinger the 2025 Outstanding Register of Deeds Award.
Reisinger’s office “became a central point of support during the county’s response” to Helene, Amanda Edwards, chair of the Buncombe County Board of Commissioners, wrote in a letter of recommendation to the N.C. Association of Registers of Deeds, the organization that selects the annual winner.
But Reisinger’s Helene-related work is only the latest example of him taking on tasks rarely associated with one of the state’s most bureaucratic and maybe even boring elected offices. He’s also worked to reduce child marriages, has mapped opioid deaths in the county and has provided diapers to low-income families.
His unconventional approach to the job is matched by his unlikely entry into the position.
Growing up in Orlando, Fla., Reisinger visited Western North Carolina for summer camp and family trips.

MORE THAN RECORDS: The main job of registers of deeds offices in North Carolina is to take care of documents about real estate transactions and births and deaths. But Buncombe County Register of Deeds Drew Reisinger has expanded his office’s mission in several different ways, including giving away diapers supplied by local nonprofit Babies Need Bottoms. Photo by Mark Barrett
He met his now-wife, Katie, while attending Appalachian State University, and the couple moved to Asheville in 2006 after graduation. Reisinger, who says he has “always found peace in the woods,” initially worked in a wilderness therapy program for troubled youths but struggled to figure out a long-term direction for his life.

that I was in love with my girlfriend and these mountains and I didn’t want to be in the D.C. rat race.”
Upon his return to Asheville, Reisinger worked on a couple of political campaigns but then planned to get out of politics. But in 2011, the county’s longtime register of deeds, Otto DeBruhl, announced his retirement in the middle of his term. DeBruhl endorsed his assistant, JoAnn Morgan, for the job; meanwhile, former state Sen. Charles Carter, then chairman of the county Democratic Party, also made a bid.
As did Reisinger, then 27, unemployed and with little experience directly related to the position. The choice to fill the vacancy rested with the county Democratic Party’s executive committee, made up of 160 or so elected officials, party leaders and precinct chairs and vice chairs.
Few expected Reisinger to win. “When a politician steps down midterm and tries to hand it over to his assistant, it’s kind of like the cake was already baked,” he says. But Reisinger’s previous campaign work had involved making ties with those same committee members. He says he convinced them that it was time for a younger person to revamp the office’s information technology. His upset win was part of a trend in which younger, more liberal leaders replaced the Democrats’ old guard in the county. The next year, Reisinger enlisted 120 people to work the polls on his behalf during the party primary, leading to a lopsided win over two fellow Democrats. He then went on to win his first full term in the general election.
Next came a job as a local organizer for Barack Obama’s 2008 presidential campaign, then a position in Washington, D.C., promoting efforts to reduce climate change. The work went well, Reisinger says, but he “realized

There were some controversies during Reisinger’s early years in office. In 2014, he was criticized for closing his office when the county got 8 inches of snow, a move that violated county policy. It didn’t help that photos of Reisinger sledding appeared on social media. Reisinger says he thought he had the commissioners’ support and maintains that the county policy made no sense. County government “can’t be telling people two different things: Stay off the roads, and we’re open for business,” he says.
There was a more muted backlash from conservatives later that year when Reisinger kept the deeds office open past 5 p.m. to issue marriage licenses the day a court decision made same-sex marriage legal in North Carolina. Only two other registers in the state did the same.
“When people need services, we help them, and this was an historic moment,” he says.
But Reisinger also made good on promises to update the office’s technology and started initiatives not usually associated with deeds offices.
His office began accepting credit cards to pay fees and taking documents for registration online. He hired bilingual employees to serve customers who speak little or no English. The office today has 17 staff members and a multimillion-dollar annual budget.
In cooperation with volunteers from UNC Asheville, the office put records of slave purchases in a separate, easily searchable section of its website in 2012. The documents are an important research tool for Black people tracing their families’ genealogy.
A more recent online project, launched in November 2021, traces the transfer of formerly Cherokee lands to white owners as part of the formation of Buncombe County. A map of opioid-related deaths in the county that Reisinger’s office produced helped the county Sheriff’s Office secure grant money for a program to help jail inmates kick opioid addiction, he says.
Reisinger has worked with fellow registers to persuade legislators to change North Carolina law on child marriage and access to birth certificates for adoptees. Currently, it takes months for the state government to provide adoptees with certificates, often necessary to get a job or government benefits, Reisinger says. As of Jan. 1, registers will be able to produce them, with parents’ names redacted, in a few minutes.
Under previous state law, people as young as 14 could get a marriage license if the bride was either pregnant or had given birth. A 2021 law raised the minimum age to 16 and put restrictions on marriages of those between 16 and 18. Reisinger says the change protects teenage girls, who research shows often become victims of domestic violence if they marry much older men.
Reisinger’s work during Helene stretched his office’s mission even more.
After clearing fallen trees on streets in his Malvern Hills neighborhood in West Asheville shortly after Helene hit, Reisinger says he visited Buncombe County’s emergency operations center to volunteer to work at a shelter for those the storm left homeless.
County Manager Avril Pinder had a different idea. She told Reisinger the county’s 911 dispatchers were “totally slammed” with calls from people who, because electricity and mobile phone service in the vast majority of the county were down, could not contact loved ones to find out whether they made it through the storm.
Pinder asked Reisinger to “create a registry of missing people,” he recalls. “I’m like, ‘That’s not actually what we do.’ And we smiled.” Then he told her, “But, I’d be glad to set up a system to achieve that.”
Reisinger and a few friends put a form online inviting people to ask for help to locate loved ones. Requests soon jumped into the thousands.
The effort quickly expanded to also deliver donated food, water, diapers, prescription medicine and even dog food to those in need, Reisinger says. “No one played by the rules. You did what you could to help your neighbors.”
Will Jernigan, a local civil engineer who was in that initial group, says the effort went surprisingly well, given the chaotic state the county was in. He notes that what became the Family Assistance Center was built from scratch over just a few hours.
It worked, he continues, partly because of Reisinger’s “magnetic leadership style. … He just kind of takes the initiative and makes it really easy to coalesce behind him.” And, “People were looking for ways to help. I think people were going through trauma, and service is a way to process trauma.”
Over a little more than a week, 2,685 volunteers checked on nearly 16,000 households and delivered more than 10,000 care packages, Reisinger says.
That whirlwind of activity — paired with toilets in the register’s office filled with feces because the city water system was down — led to the establishment of a flush patrol.
Reisinger and an employee “had this ‘Aha!’ moment,” he says. “If this is what’s happening here, I know at Aston Park Tower there’s a grandma on the seventh floor who is in a wheelchair and the elevator is off with no electricity, and you know her toilet is backed up as well.”
Volunteers then began visiting apartment buildings to flush toilets.
In a social media video, Reisinger demonstrated how to use a 5-gallon bucket of water to do the job. Friends jokingly called it “the Reisinger method”: Pour directly into the bowl, not the tank. Start out slowly, finish quickly.
That project eventually became part of a separate volunteer group with the same mission, Flush AVL.
The deeds office, located on College Street downtown, is quieter now but still offers more than the usual records and documents. It recently hosted an exhibit of photos of joyful scenes from the first day that Reisinger was able to issue marriage licenses to same-sex couples and, in cooperation with the nonprofit Babies Need Bottoms, offers free diapers to families in need.
At 42, Reisinger is in his fourth full term in the deeds job and won reelection in 2020 and 2024 without opposition. He says he is not looking to move up to higher office. Rather, he says he asks himself, “How does this office stay relevant, and how do we move this community forward?” X


through
31st

17 - JAN. 1, 2025
For a full list of community calendar guidelines, please visit mountainx.com/calendar. For questions about free listings, call 828-251-1333, opt. 4. For questions about paid calendar listings, please call 828-251-1333, opt. 1. Online-only events
More info, page 46-47
Candlelight Flow Yoga
Unwind in our all-levels Candlelight Flow Yoga class.
SU (12/21, 12/28), 5pm, Happy Body Pilates, 25 Reed St., Suite 210
Community Kirtan & Song Circle
Experience the joy and connection of kirtan, a heart-centered gathering where we come together to sing devotional chants in a call-and-response format.
SU (12/21, 12/28), 6:30pm, The Well, 3 Louisiana Avenue
Kin ē sa Mat Class
Kin ē sa focuses on retraining the brain and calming the nervous system to release habitual patterns of posture, movement, and body mechanics.
TU (12/23, 12/30), 8:30am, Happy Body Pilates, 25 Reed St., Suite 210
Sunday Morning Meditation
A combination of silent sitting and walking meditation, facilitated by Worth Bodie, a longtime Buddhist student and practitioner.
SU (12/21, 12/28), 10am, The Lodge at Quietude, 1130 Montreat Rd
Wellness Wednesdays: Cue The Pub Run Come for the run and stay for the beer. The perfect way to make new connections or keep current ones fresh.
WE (12/17, 12/24, 12/31), 6pm, Archetype Brewing, 265 Haywood Rd
SharQui Bellydance Fitness
A bellydance fitness class suitable for all levels, led by instructor Kim Reigle.
WE (12/17, 24, 31), noon, SA (12/20, 27), 10am, World Dance Asheville, 1269 Tunnel Rd
Intro to the Fitness Center
Tour the Stephens-Lee fitness center and learn how to use each machine and receive lots of encouragement to keep you on track.
TH (12/18), 1pm, Stephens-Lee Rec Center, 30 George Washington Carver Ave
Quantum Energy Healing & Transformation: Group Session w/Meg Connect in the quantum field to release limitations, clear trauma imprints, resolve imbalances, expand your gifts, find deeper alignment to spirit, create your dreams & embody more light.
TH (12/18), 7pm, The Well, 3 Louisiana Avenue
More info, page 48 In Celebration of 40 Years

LIGHT THE NIGHT CELEBRATION: A Winter Solstice Lantern Walk starts at the Marquee in the River Arts District on Saturday, Dec. 20, with pre-festivities beginning at 5 p.m. Bring your own lantern to this community celebration that also features music from the Resound Community Choir and lantern-making classes from Street Creature Puppet Collective. Photo courtesy of Light the Night
Wild Souls Authentic Movement Winter Solstice Class
A supportive environment for an expressive movement class designed to help you get unstuck, enjoy cardio movement, boost immune health, dissolve anxiety and more.
SU (12/21), 9:30am, Dunn’s Rock Community Center, 461 Connestee Rd, Brevard Winter Solstice Sound Bath
An Open Reading Event
12/19: Get published online with Joe Marich
12/21: Writing Memoirs with Karen Ackerson, 1-5pm
3/3: Literary fiction contest deadline! December 20, 2025
3-5pm in Activity Room at Pack Memorial Library
During the meditation, you’ll experience the energies of the stars and the gentle warmth of the rising sun as
its healing rays bathe your body in peace and renewal.
SU (12/21), 1pm, Community Commons at CSL Ashevile, 3 Sciene Mind Way
Community Yoga w/ Carrie
A free hour of yoga, meditation and mindfulness with local yoga instructor.
WE (12/24), 10:30am, AmeriHealth Caritas NC Wellness and Opportunity Center, 216 Asheland Ave
Doom Metal Yoga with Quantum Mystic Doom metal Yoga will be a slower paced

yoga class connecting movements with the breath. There will be an emphasis on alignment and cultivating a sense of presence while listening to doom.
MO (12/29), 6:30pm, Eulogy, 10 Buxton Ave
Carolina Resource Center for Eating Disorders Support Group
This support group is peer-led and facilitated by licensed therapists & dietitians specializing in eating disorders. To learn more about participation visit avl.mx/es6.
WE (12/17, 12/31), 6pm, Online
Families Anonymous Support group for those affected by someone else’s addiction. We support each other with support of program.
TU (12/23, 12/30), 6pm, Love & Respect, 350 Chadwick Ave Suite 300
Nicotine Anonymous People share their experience, strength and hope to stop using nicotine. You don’t need to be stopped, just have a desire to attend.
TH (12/25, 12/18, 1/1), 4:30pm
Staying Grounded in Shaky Times
A spiritual practice, support, and discussion group for seekers. It will explore a variety of spiritual practices including meditation, breath-work, meditative movement and more.
WE (12/17, 12/24, 12/31), 2pm, AmeriHealth Caritas NC Wellness and Opportunity Center, 216 Asheland Ave
The Men’s Nest Make meaningful human connections to strengthen your social health, cultivate compassion, and learn
to use your power to give and receive authentic support.
TU (12/23, 12/30), 5:15pm, SeekHealing, 50 S French Broad Ave
Anxiety Support Group
A support group for people experiencing anxiety.
TH (12/18), 6pm, NAMI- WNC, 356 Biltmore Ave
Marijuana Anonymous
Whether you’re exploring sobriety, new to recovery, or have been on this path for a while, you are welcome here.
TH (12/18), 6:30pm, American Legion Post, 851 Haywood Rd
Menopause Matters
Come as you are, bring a friend and engage in a real discussion about midlife changes with a welcoming group of women who “get it”.
TH (12/18), 5:30pm, AmeriHealth Caritas NC Wellness and Opportunity Center, 216 Asheland Ave
Winter Women
Meeting
Monthly meeting for mature women to discuss and study Celtic Spirituality.
TH (12/18), noon, First Congregational Church of Christ of Asheville, 20 Oak Street
Intuition And Mediumship Practice Circle
The circle will include exercises to develop our skills, practice readings, and discussions about all things spirit- and intuition-related.
TU (12/23), 7pm, The Well, 3 Louisiana Avenue
Magnetic Minds: Depression & Bipolar
Support Group
A free weekly peer-led meeting for those living with depression, bipolar, and related mental health challenges. For more information contact (828) 367-7660. SA (12/27), 2pm, First Congregational Church of Christ of Asheville, 20 Oak St
Bellydance Drills - All Levels
A class focusing on bellydance drills suitable for all levels, led by Olivia Blahowsky.
SU (12/21, 12/28), 4pm, World Dance Asheville, 1269 Tunnel Rd
Country Line Dance w/ Kristey
Featuring beginner and advanced classes that are open to everyone. Dust off your favorie boots, and get ready to groove.
WE (12/17, 12/24, 12/31), 6pm, Eda’s Hide-a-Way, 1098 New Stock Rd, Weaverville
Latin Night Wednesday w/DJ MTN VIBEZ
A Latin dance social featuring salsa, bachata, merengue, cumbia, and reggaeton with dance lessons for all skill levels. Open dance is from 9 p.m. to midnight.
WE (12/17, 12/24, 12/31), 8pm, One World Brewing West, 520 Haywood Rd
Fundamentals of Bellydance
Explore the fundamentals of bellydance, focusing on internal

movement, isolations, smooth travel, hip articulation, and fluidity.
WE (12/17), 5:30pm, The Well, 3 Louisiana Avenue
ART
Artful Living: The Spirit of the Craftsman Style
Through clay, canvas, wood, and metal, Artful Living explores the soul of the Craftsman ethos—simplicity, utility, and harmony with the natural world.
Gallery open Monday through Sunday, 10am. Exhibition through Dec. 31. Grovewood Gallery, 111 Grovewood Rd
Lasting Legacies:
Architecture in Asheville by Richard Sharp Smith, Albert Heath Carrier & Douglas D. Ellington
Lasting Legacies shines a spotlight on the contributions of two of the city’s most prominent architectural firms to Asheville’s built environment and artistic spirit in the early decades of the 20th century. Gallery open Wednesday through Sunday, 11am. Exhibition through Jan. 18, 2026.
Asheville Art Museum, 2 S Pack Square
Blue Star Gallery
Holiday Open House
Blue Star invites you to their first annual holiday open house. It will feature seasonal goodies, drinks and a selection of artists and authors.
SA (12/20), SU (12/21), 11am, Blue Star Gallery, 867 Haywood Rd
Holiday Bizarre Group Art Show
Artists were encouraged to explore winter, holiday, sci-fi, horror, rock & roll, and psychedelic themes. Expect a wider variety of paintings, collages, ink drawings and more. Gallery open Sunday thtough Thursday, noon. Exhibition through Jan. 11.
Push Skate Shop & Gallery, 25 Patton Ave Public Tour: Discovering Art in Asheville Volunteer educators or Museum staff will lead an interactive tour.
SU (12/21, 28), 3pm, Asheville Art Museum, 2 S Pack Square
Public Tour: Featured Exhibition
A guided tour of the museum's current featured exhibition.
SA (12/20, 27), 2pm, Asheville Art Museum, 2 S Pack Square
Slow Art Friday
Experience how close looking can foster relaxation and connection.
FR (12/19, 26), noon, Asheville Art Museum, 2 S Pack Square
Trolls: A Field Study
An interactive exhibition featuring twelve troll sculptures exploring human life, crafted from materials like fallen branches and wooden pallets. Open daily, 8am.
NC Arboretum, 20 Frederick Law Olmsted Way
Look Homeward, Angel: Letterio Calapai’s Wood Engravings of the Asheville-Inspired Novel
This exhibition pres-




ents a folio of prints by Letterio Calapai illustrating "Look Homeward, Angel" (1929)—Thomas Wolfe’s semi-autobiographical novel set in a fictionalized Asheville. Gallery open Wednesday through Sunday, 11am. Exhibition through Feb. 22, 2026.
Asheville Art Museum, 2 S Pack Square
Modern Bestiary: Creatures from the Collection
This exhibition explores the artistic legacy of the medieval bestiary through a selection of animals and fantastic beasts from the Museum’s Collection. Gallery open Wednesday through Sunday, 11am. Exhibition through March 15, 2026.
Asheville Art Museum, 2 S Pack Square
Women of the Pacific Northwest
This exhibition celebrates the voices, visions and material mastery of female artists working today, with roots from this rich and progressive region. Gallery open Wednesday through Sunday, 11am. Exhibition through May 17, 2026.
Asheville Art Museum, 2 S Pack Square
Asheville based music with VISUALS' line of herbal wines.
TH (12/18), 7pm, Eulogy, 10 Buxton Ave
Pan Harmonia: Yuletide
Now an annual tradition, Kate Steinbeck and Jessica Schaeffer bring the soothing, light-filled sounds of flute and harp to the darkest days of the year.
FR (12/19), noon and 4pm, St. Matthia Church, 1 Dundee St
Christmas Carols
Prepare your hearts for Christmas with beloved carols and readings that proclaim the wonder of Christ’s birth.
SU (12/21), 5pm, Alexander Chapel United Methodist Church, 880 Aiken Rd
Lessons & Carols
Featuring scriptural readings that unfold the story of the saviour, inspiring choral music and carols led by our choir and professional brass ensemble.
SU (12/21), 5:30pm.
Trinity Episcopal Church, 60 Church St
Asheville Jazz Orchestra’s Christmas Show w/Wendy Jones
Crafting Your Business Plan: Marketing In this session you will learn how strong marketing is critical to make your business thrive. Attendees will learn how to understand the market for your business—from your customer to your competition. Register at avl.mx/f86.
WE (12/17), 10am, Online
Crafting Your Business Plan: Financials In this session, you will work on the operations and the important financial sections of the Business Plan. Learn why businesses borrow money, what lenders are looking for when reviewing your application, and the importance of having cash flow projections. Register at avl.mx/f85.
TH (12/18), 10am, Online
Stamp a Copper Ornament
Come stamp a copper ornament, or earrings to your liking. Choose from more than 50 styles of metal stamps and a variety of jewelers hammers to complete your charm.
have time to complete your masterpiece.
TU (12/23), WE (12/17, 12/24, 12/31), 11am, Ignite Jewelry Studios, 84 Walnut St Unit A
Flooded Poetry Mondays
Poetry-specific open mic, starring you plus weekly featured readers, every Monday. MO (12/22, 12/29), 6:30pm, Flood Gallery, 802 Fairview Rd, Ste 1200
Poetry Open Mic Asheville's longest-running open mic, welcoming all forms of creative expression. Sign-up at 8 pm for a 5 or 10 minute spot.
WE (12/17, 24, 12/31), 8:30pm, Sovereign Kava, 268 Biltmore Ave
Asheville StorySLAM: Family Matters Prepare a five-minute story about the people you’re bound to by blood, marriage, or choice. Siblings, in-laws, step-relatives, or the chosen family who showed up when it mattered most.
TH (12/18), 7:30pm, The Grey Eagle, 185 Clingman Ave World Affairs Book Club







UNCA Jazz w/Bill Bares
A night of incredible jazz with pianist, composer, scholar and educator William Bares, a professor or music and co-director of jazz studies at UNC Asheville.
WE (12/17), 7pm, White Horse Black Mountain, 105C Montreat Road


VISUALS Solstice Celebration w/ Rodent
They create seasonal, take home rituals focused on pairing
Get ready for classic holiday tunes, bold brass, smooth swing, and festive cheer—all wrapped up in one unforgettable night.
SU (12/21), 7:30pm, White Horse Black Mountain, 105C Montreat Rd, Black Mountain
Jazz & Soul Sessions w/Kelle Jolly & Will Boyd
A vibrant new concert series featuring nationally acclaimed artists Kelle Jolly and Will Boyd, making up a dynamic five member house band.
FR (12/26), 7pm, SA (12/27), 3pm, YMI Cultural Center, 39 S Market St

TH (12/18), FR (12/19), SA (12/20), TU (12/23), WE (12/24), 11am, Ignite Jewelry Studios, 84 Walnut St Unit A
Simply Charmed & Copper Ornament
Making
Choose from more than 60 styles of metal stamps and a variety of jewelers hammers to complete your charm. FR (12/19), SA (12/20), 11am, Ignite Jewelry Studios, 84 Walnut St Unit A
Simply Charmed: Drop In Workshop
Choose from more than 60 styles of metal stamps and a variety of jewelers hammers to complete your charm. After a quick demo by the instructor you will
Where passionate readers and engaged citizens delve into thought-provoking books.
TH (12/18), 10am, Transylvania County Library, Brevard, 212 S Gaston Street
Christmas Storytime by the Fire
This free program is full of Christmas cheer, and will include three readings of winter and holiday-themed picture books for young learners and seasonal fun for the whole family.
SA (12/20), 9am, Vance Birthplace, 911 Reems Creek Rd, Weaverville The Writer's Workshop of Asheville: An Open Reading In celebration of 40
years, the Writer's Workshop of Asheville will be hosting an open reading event inviting all writers, poets and literary artists to come participate.
SA (12/20), 3pm, Pack Memorial Library, 67 Haywood Rd
Black Experience Book Club
This community-centered series is designed to explore literature that centers the voices, histories, and futures of the African Diaspora.
TH (12/25), 6:30pm, YMI Cultural Center, 39 S Market Street
Random Act Productions Presents: A Christmas Carol
A story of redemption and the power of the holiday spirit, it is also a celebration of the theatre, where virtuosic acting and a commitment to the power of storytelling brings us all closer together.
WE (12/17), TH (12/18), FR (12/19),
SA (12/20), 7:30pm, FR (12/19), SU (12/21), 2pm, NC Stage Co., 15 Stage Lane
Dashing Through the Snow
Four days before Christmas in Tinsel, Texas, a colorful parade of eccentric guests arrive at the Snowflake Inn and deck the halls with holiday hilarity.
FR (12/19), 7:30pm, SA (12/20), SU (12/21), 3pm, Foreign Film Friday: Cosy Dens
Two families, Sebkovi and Krausovi, are celebrating Christmas, but not everyone is in a good mood. The teenage kids think that their fathers are totally stupid, and the fathers are sure that their children are nothing more than rebels, hating anything they say.
FR (12/19), 7pm, Flood Gallery, 802 Fairview Rd
The Best Christmas Pageant Ever
A hilarious, heartwarming holiday play where the unruly Herdman kids crash the annual Christmas pageant and turn chaos into unexpected Christmas magic.
FR (12/19), SA (12/20), 7:30pm, SU (12/21), 2pm, Hart Theatre, 250 Pigeon St
Foreign Film Friday: Cronos
Kindly antiques dealer Jesús Gris happens upon an ancient golden device in the shape of a scarab, and soon finds himself the possessor and victim of its sinister, addictive powers, as well as the target of a mysterious American named Angel.
FR (12/26), 7pm, Flood Gallery, 802 Fairview Rd
Social Seniors
A social gathering for seniors to engage in various activities and connect with peers. Monday through Friday, 9am. Grove Street Community Center, 36 Grove S
Winter Solstice w/ Mother Grove
Goddess Temple
Please bring noisemakers (bells, jingles, drums, etc) to help ring in this festive time. We also invite you to bring shelf-stable food donations for our growing community food pantry.
FR (12/19), 7pm, Haw Creek Commons, 315 Old Haw Creek Rd
Atheists of WNC
This little Atheist group invites anyone who doesn't believe in religions to come chat with like-minded people. Find out more at avl.mx/f8c.
SU (12/21, 12/28), 10am, EarthFareWestgate, 66 Westgate Pkw
Coloring w/Cats
Take 50 minutes for yourself and cuddle with the panthers, meet other cat-lovers, and color a beautiful picture of a cat from our adult coloring books.
SU (12/21, 12/28), 2pm, House of Black Cat Magic, 841 Haywood Rd.
Tails & Ales: Dog Friendly Community Hangout
Bring your pup, grab a beer, and hang out with other local dog lovers.
WE (12/17, 12/24, 12/31), 5pm, Hi-Wire RAD Beer Garden, 284 Lyman St
APR's 12 Days of Magic: Cookie Exchange
Unwrap a new holiday surprise each day to celebrate the magic and wonder of the season.
WE (12/17), 2pm, Grove Street Community Center, 36 Grove S



Southside Cyber Wednesday
Dive into the exciting world of e-sports and gaming with friends and neighbors with two powerful PlayStation 5 consoles ready for action.
WE (12/17), 6pm, Dr. Wesley Grant Sr. Southside Community Center, 285 Livingston St
APR's 12 Days of Magic: Holiday Minute to Win It
Unwrap a new holiday surprise each day to celebrate the magic and wonder of the season.
TH (12/18), 2pm, Grove Street Community Center, 36 Grove St
APR's 12 Days of Magic: Christmas Carol Karaoke
Unwrap a new holiday surprise each day to celebrate the magic and wonder of the season.
FR (12/19), 2pm, Grove Street Community Center, 36 Grove St Sunday Worship Service
Weekly Sunday worship service.
SU (12/21, 12/28), 11am, Warren Wilson Presbyterian Church, 101 Chapel Ln, Swannanoa
APR's 12 Days of Magic: Holiday Movie & Hot Chocolate
Unwrap a new holiday surprise each day to celebrate the magic and wonder of the season.
MO (12/22), 2pm, Grove Street Community Center, 36 Grove St
APR's 12 Days of Magic: Gift Exchange
Unwrap a new holiday surprise each day to celebrate the magic and wonder of the season.
TU (12/23), 2pm, Grove Street Community Center, 36 Grove St
Somatic Healing Circle
In this monthly exploration, you will learn to develop practical tools to
heighten awareness of how you experience, embody, and express yourself in the world.
MO (12/29), 6:30pm, The Lodge at Quietude, 1130 Montreat Road
Adult Community Basketball Come shoot some hoops or play a pick up game with friends.
SU (12/21, 12/28), 1pm, Dr. Wesley Grant Sr. Southside Community Center, 285 Livingston St
Asheville Board Game Club Meetup
Play a wide variety of games—strategy, party, cooperative, and more.
WE (12/17, 12/24, 12/31), 5:30pm, Well Played Board Game Café, 162 Coxe Ave, 101
Homeschooler’s Hangout Games help develop cognitive skills, including decision-making, problem-solving, and logical analysis. In older adults, playing games has been shown to lower the risk of developing Alzheimer’s disease.
TH (12/18, 12/25, 1/1), 11am, Well Played Board Game Café, 162 Coxe Ave, 101
Hooping Around Community Basketball Come show your skills, play a pick-up game, and get a good sweat in during our Community Basketball.
SU (12/21, 12/28), 1:15pm, Linwood Crump Shiloh Community Center, 121 Shiloh Rd
Magic: The Gathering Whether you’ve been playing for years or are just starting your journey, this is your chance to battle, brew, and build community.
TU (12/23, 12/30), 6pm, Well Played Board Game Café, 162 Coxe Ave, 101
Monday Night Music Video Bingo
Come out for Monday night music video bingo with Jason.
MO (12/22, 12/29), 6pm, Mills River Brewing Co., 336 Banner Farm Rd, Mills River Pool Night Pool night, every Monday night with a $5 buy in. Must be signed up by 7 p.m.
MO (12/22, 12/29), 6:30pm, Eda’s Hide-aWay, 1098 New Stock Rd
Southside After Praise After church, enjoy an afternoon playing spades or dominoes.
SU (12/21, 12/28), 1:30pm, Dr. Wesley Grant Sr. Southside Community Center, 285 Livingston St
Weekly Sunday Scrabble
If you like Wordle, Boggle, Words with Friends or Scrabble online, this club may be a good fit for you. All of the games are provided.
SU (12/21, 12/28), 1:30pm, Stephens-Lee Rec Center, 30 George Washington Carver Ave
Chef Life Radio: Live Podcast Series w/ Adam Lamb
SU (12/21), 6pm, The Mule, 131 Sweeten Creek Road St. 10
Ping Pong Tournament
Come by and shoot your shot against some of the best ping pong players in town. Free to enter and $50 bar tab to the winner.
MO (12/22, 29), 6pm, Sovereign Kava, 268 Biltmore Ave
Game Designers of NC Meetup
Come playtest the next generation of games.
TU (12/23), 6pm, Well Played Board Game Café, 162 Coxe Ave, 101
Game Night
An evening of cards and games such as dominoes and Rummikub.
TH (12/25), 7pm, First Congregational Church of Christ of Asheville, 20 Oak Street
Baby Story Time
A lively language enrichment story time designed for children ages 4 to 18 months.
TH (12/18, 12/25, 1/1), 10:30am, Oakley/South Asheville Library, 749 Fairview Rd
Coloring w/Cats: Kiddie Edition
Coloring books and markers (and of course, cats) are provided for this relaxing artistic session. Children ages 13 and under are welcome to this event.
SA (12/20, 12/27), 1pm, House of Black Cat Magic, 841 Haywood Rd
Black Cat Tales: Story Time w/Cats
Families with children age 7 & under are invited to relax in the cat lounge and listen to a cat-centric book surrounded by our resident panthers.
WE (12/17), TH (12/18), FR (12/19, 12/26), 4pm, House of Black Cat Magic, 841 Haywood Rd
Jingle Bell Toddler Party
Jingle bells, reindeer magic, and a snowball toss are part of the celebration in the magical Castle on the Hill packed with inflatables, toys, activity stations, and festive refreshments.
WE (12/17), 10am, Stephens-Lee Rec Center, 30 George Washington Carver Ave
Paws & Pages
Children can drop in to the kids area and read aloud to a furry pal! The Library uses volunteers and therapy dogs from the 5 Paws Therapy Group.
WE (12/17), 4pm, Transylvania County Library, Brevard, 212 S. Gaston Street











































Kids Eat & Paint
A family-friendly event where kids can eat and paint for free.
MO (12/22), 5pm, Moe’s Original BBQ, 72 Weaverville Rd
Kid Hop Hooray
A family friendly dance party for little dancers. It will feature plenty of room to run and dance with snacks available for purcahse.
SA (12/27), 10am, The Orange Peel, 101 Biltmore Ave
Weaverville Tailgate Market
This market features a selection of fresh, locally grown produce, grass fed beef, pork, chicken, eggs, cheese, baked goods, artisan bread, eclectic handmade goodies, garden and landscaping plants.
WE (12/17, 24, 31), 3pm, 60 Lake Shore Dr Holly Jolly Christmas Markets
Shop local and discover beautifully crafted, artisan-made gifts, paintings, jewelry, and t-shirts to handmade chocolates, baked goods and more.
SA (12/20), 10am, White Horse Black Mountain, 105 Montreat Rd, Black Mountain
Holiday Bulb Market
This market will feature several different types of big amaryllis bulbs, two kinds of paperwhite bulbs, potted plants, assorted greens, holiday bouquets and more.
SA (12/20, 27), 9am, Bloom WNC Flower Farm, 806 N Fork Rd
Junk-O-Rama Vintage Market
Full bad, vintage clothes, jewelry, local art & more.
SU (12/21, 12/28), noon, Fleetwood’s, 496 Haywood Rd
Honky Tonk Flea
Discover unique antique treasures, vintage gems, and
handmade goods while listening to the best honky tonk vinyls.
SU (12/21), 12am, Eda's Hide-a-Way, 1098 New Stock Rd, Weaverville
The Black Cat Market
This event will be at an indoor venue. Grab a drink, and enjoy a day of shopping nostalgia- or find the perfect holiday gift for a loved one!
SU (12/21), 11am, Eulogy, 10 Buxton Ave
WNC Farmers Market
Open 7 days. This year-round market features locally grown produce, fruits and vegetables, mountain crafts, plants, shops, arts and crafts, sourwood honey, and other farm fresh items.
Open daily, 8am. 570 Brevard Rd
Winterfest & Christmas Light Show Drive through an extravagant, 2-mile Christmas light show, synchronized to music.
WE (12/17), TH (12/18), FR (12/19), SA (12/20), SU (12/21), MO (12/22), TU (12/23), 11am, Tryon International Equestrian Center, 25 International Blvd
Winter Lights Trolley
Enjoy all that Biltmore Park Town Square has to offer, and take our Trolley to see the lights.
FR (12/19, 12/26), SA (12/20, 12/27), 5:30pm, NC Arboretum, 20 Frederick Law Olmsted Way
Ballet Conservatory of Asheville Presents: The Nutcracker A magically festive, full-length Nutcracker, featuring professional classical dancers and the Ballet Conservatory’s celebrated pre-professional company.
TH (12/18), 4:30pm, FR (12/19), 4:30pm,

7:30pm, SA (12/20), 10am, Wortham Center for the Performing Arts, 18 Biltmore Ave
Candy Cane Flashlight
Hunt
Search for candy canes and merry treasures in the dark. Bring your own flashlight or head-lamp.
TH (12/18), 5:30pm, Carrier Park, 220 Amboy Road
Third Thursday
An evening filled with music, tours, art making, special cocktails in the rooftop café, and more.
TH (12/18), 5pm, Asheville Art Museum, 2 S Pack Square
Christmas in Appalachia: A Singin', Strummin', Family Show
Experience the beauty of seasonal music played on traditional Appalachian instruments, and sing along to everyone’s favorite holiday tunes. It will feature music from old-time musician Travis Stuart, actor/storyteller John Hall and friends.
FR (12/19), 7:30pm, SA (12/20), 2pm, 7:30pm, SU (12/21), 2pm
Reindeer Romp
This celebration takes over town across 8 Black Mountain Bars and the party will continue at White Horse. It will feature a night of costumes, karaoke, DJ after-party with DJ Aoili, drink and food specials, decorations and more.
FR (12/19), 5pm, White Horse Black Mountain, 105C Montreat Rd
Winter Solstice Lantern Walk
A community-wide Winter Solstice Lantern Walk that began as a heartfelt offering of hope after Hurricane Helen and has grown into a beloved gathering that brings hundreds together in light, creativity and community spirit. It will feature music from the Resound Community
Choir, community festivities and more. SA (12/20), 5pm, The Marquee, 36 Foundy St
A Swannanoa Solstice
A holiday event featuring music and storytelling. SU (12/21), 7pm, Wortham Center for the Performing Arts, 18 Biltmore Ave
Winter Solstice
The night will include cookie donation packing, a solstice ceremony, and the cumulation of the Winter Gear Drive.
SU (12/21), 5pm, Olivette Community Farm, 1069 Olivette Rd
Grinch's Grub
A whimsical Grinchthemed indoor picnic and movie viewing inspired by the beloved Dr. Seuss classic about a cranky, solitary creature who realizes that Christmas is not all about money and presents.
SU (12/21), 2pm, Tempie Avery Montford Community Center, 34 Pearson Dr
Atheists of WNC Present: Festivus Party Meet and chat with other people who don't believe in religion or almighty gods, if you are looking to get away from the Christmas commercialism and stress. It will feature games, pizza, conversations and more. See p46-47 TU (12/23), 5:30pm, Pack Memorial Library, 67 Haywood Rd
The Music of a Charlie Brown Christmas w/Dr. Bill Bares & the Constellations Orchestra
The Constellations Orchestra and Dr. Bill Bares interpret this masterpiece with the warmth and wonder of Christmas, bringing Charlie Brown, Snoopy, and the entire Peanuts gang to life through music. See p48 TU (12/23), 3pm, Wortham Center for the Performing Arts, 18 Biltmore Ave



Home for the Holidays: Christmas Eve by the Fire
Rev. Suzi and OneVoice lead a cozy Christmas Eve by the fire, filled with the warmth of holiday music and the inspiring Christmas story of “The Other Wise Man".
WE (12/24), 5:45pm, Community Commons at CSL Asheville, 3
Science of Mind Way
Christmas Day Music & Meditation
Immerse yourself in gentle music and soothing meditation designed to nurture you into a calm, open-hearted, and loving spirit for the festivities of the Holiday Season.
TH (12/25), 11am, Community Commons at CSL Asheville, 3
Science of Mind Way
Holiday Potluck Dinner
Finish the year with more fun, food, and fellowship.
SU (12/28), noon, Fellowship Hall, 756 Fairview Road
New Year's Eve w/ Jaenga, Notixx, Poser & More
Countdown the New Years with a stacked lined up of Electronic Dance Music artists
and headliner Jaenga on his Dream Machine Tour.
WE (12/31), 6pm, Sly Grog, 271 Haywood St NYE Jazz Jubilee
This celebration features soft lights, rich colors, a little sparkle in the air, and live jazz that makes the whole room feel like it’s humming. Ease into the night with Meschiya Lake who will be bringing vintage charm and smooth swing and a NYE countdown too.
WE (12/31), 5:30pm, Fitz and the Wolfe, 1 Battery Park
Billy Jonas Band “Welcome the New Year” Family Concert
Whether performing for adults, families, school groups, faith communities, or a mix, they strive for a musical excellence that inspires, entertains, and moves people literally and figuratively.
WE (12/31), 1pm, The Grey Eagle, 185 Clingman Ave
New Year’s Resolution Run 5k & 10k
Hit the ground running in 2026 with the 12th annual New Year’s resolution Run 5k and 10K. The race course takes you through the bustling streets of
downtown and charming neighborhoods.
TH (1/01), 10am, Pack Square Park, 80 Court Plaza
No Cost Veggie & Fruit Share Market
Access delicious, nutritious fruits and vegetables at absolutely no cost sourced from Bountiful Cities Gardens and MANNA FoodBank.
WE (12/17), 3pm, Tempie Avery Montford Community Center, 34 Pearson Dr MANNA Holiday Food Distribution
This event will provide boxes of free groceries. Each box will include a variety of nutritious items such as fresh produce, meat, eggs and dry foods — enough to help families enjoy a full holiday meal.
TH (12/18), 2pm, WNC AG Center, 761 Boylston Hwy, Fletcher
Sh4rk-Mass a Hiphop Toy Drive
A Hiphop show where the entry fee is a toy donation for ages 1 through 17 years old. All toys that are col-
lected will be donated and distributed by Beloved Asheville.
TH (12/18), 7pm, The Odd, 55 College St Red Cross Blood Drive
Everyone who donates blood will receive an exclusive long-sleeved Red Cross t-shirt.
FR (12/19), 1pm, 12 Bones Brewing Smokehouse & Brewing, 2350 Hendersonville Rd
Home for the Holidays FUNdraiser
This special fundraiser offers an evening of holiday cheer: Santa, face painting, live music, silent action, entertainment, free food and ice cream, beverages and more. Every dollar raised will go directly to support the following 5 incredible, local nonprofits.
SA (12/20), 5pm, The Orange Peel, 101 Biltmore Ave
Beer & Hymns
Beer & Hymns brings people together to raise a glass and a voice while raising funds for organizations that change the world.
MO (12/22), 7:30pm, White Horse Black Mountain, 105C Montreat Rd, Black Mountain














GRAND FINALE: More than 30 people showed up to celebrate the last official meetup of the Year in Beer project. The tradition
however, every Wednesday at 5:30 p.m. at Wedge at Foundation. Photo by Christopher Arbor
CHRISTOPHER ARBOR
On Jan. 1, Christopher Arbor and his friends pledged to visit one Asheville brewery each week for all of 2025 in the order that they opened, then share the experience with Mountain Xpress readers.
To read about Christopher’s solo visit to MadCo Beer Company in Marshall, visit avl.mx/f8n.
Is there a word in the English language more emotionally resonant than home?
Trey and I arrived at the recently reopened Wedge at Foundation at the same time: right on time. We stepped through the doors into the warm, familiar space — a place that, like so many of us, was nearly destroyed just over a year ago, refused to give up and is now “stronger in the broken places,” as Hemingway promised we could be.
I noted the highwater mark on the wall, well over my head. I also noted the clink of glasses, the smell of hops and the faces of a dozen friends, new and old, who had arrived early for our celebration.
I said to Trey, “You know where I wish I was right now?”
He smiled, knowing full well the answer before I finished asking it. “Right here.”
“Damn straight.”
We joined the crowd. Hugs and highfives abounded.
The vibe was like a hoppy lager: bittersweet. For a year, our adventure to visit local breweries has been like a snowball rolling downhill, gaining momentum and growing in mass as new members joined our visits and read our weekly write-ups. And here we were, at the journey’s end.
Another dozen people arrived. Then a dozen more. What started as four or five us had grown to over 30. Drinking buddies are, after all, like Jell-O — a little wobbly, but there’s always room for more.
At some point, Alan knowingly handed me a pint of the AOB stout, which I took gratefully. I’d been there an hour and had been so lost in conversation and camaraderie that I hadn’t even ordered a beer yet.
That AOB stout is my favorite beer in all the world. But, folks, let me tell you something about this series that you may already know if you’ve been paying attention: It’s not about beer. It never was.
I couldn’t help but think of a T.S. Eliot line that has long puzzled me, one that I think I had finally come to understand: “And the end of all our exploring will be to arrive where we started and know the place for the first time.”
I’ve written 50 “Year in Beer” articles in 50 weeks, and the brews have always been just a vehicle — a metaphor. What’s it all really about? If you’re a longtime reader, you know. It’s not about the beer
Alan handed me; it’s about the fact that he noticed I was empty-handed.
This has been a series about the alchemy of community, the way that our gathering like the beer we drink is more than the sum of its parts.
Whether you’re a regular attendee, a regular reader or are just now learning of our endeavor, this series is about you. All of you. And — more importantly — it’s about us. All of us. It’s the fact that we’re stronger together, better able to face challenges and celebrate successes.
David interrupted my reverie to hand me a gift — a Wedge T-shirt with the text “Est. 2017 + 2025.” I hugged him and admittedly cried a little, because those two dates are what this series is about: establishing and then reestablishing community.
Even a long life is too short, so this series has always been about reveling in whatever time we have together. It’s about holding dear to what matters most, rebuilding what we can and letting go of what we can’t.
Our yearlong brewery crawl is over. However, our community is still rebuilding, and our friendships are still deepening. We’ll continue gathering every Wednesday at 5:30 p.m. at the Wedge at Foundation, and you, dear reader, are still invited.
See you there. Raise a glass. X








Village Wayside Bar & Grille, a staple of Biltmore Village that was destroyed during Tropical Storm Helene, will reopen in Grovewood Village. The restaurant is aiming for a late winter debut in the former ELDR space, which also closed in the wake of last year’s natural disaster.

“Although we will forever cherish the memories of our time in Biltmore Village in the iconic old train depot, we are excited to embrace this new chapter as a chance to rebuild, grow, and connect with the community,” says owner Mark Harding in a press release. “We can’t wait to welcome back our loyal patrons of many years and introduce the Wayside to the North Asheville community.”
The move also holds historical significance. Grovewood Village was originally constructed as the base for Biltmore Industries’ weaving and woodworking operations. The company was founded in 1905 in Biltmore Village with support from Edith Vanderbilt. Fred Loring Seely, sonin-law of Grove Park Inn visionary Edwin Grove, bought it in 1917 and relocated it to Grovewood Village. Biltmore Industries closed in 1981 and is now the site of the Homespun Museum, featuring artifacts from the active years of the industry.
To learn more, visit avl.mx/f8d.
Prepaid health plan AmeriHealth Caritas North Carolina is making a $5 million, multiyear community investment to help MANNA FoodBank build more sustainable access to nutritious food and strengthen local growers in Western North Carolina through the nonprofit’s Essential Foods Program. The initiative focuses on providing the community with nutrient-dense staples such as meat, eggs and cheese, as well as fresh produce.
The money will additionally help replace and improve strategic infrastructure and foster the development of community hubs, which MANNA will use to aggregate and distribute food to its 225-plus partner organizations that serve families across 16 counties and the Qualla Boundary. The program sources as many of its purchases as possible from farmers in the region while increasing food access for children, seniors, veterans and working families.
“This extraordinary commitment from AmeriHealth Caritas North Carolina is an investment in health, sta-
bility and local resilience,” says Claire Neal, CEO of MANNA FoodBank, in a press release. “Together, we will deliver more of the most essential foods families ask for and strengthen the local network that makes long-term food security possible for our region.”
To learn more, visit avl.mx/f8e.
OWL Bakery North Asheville has added a cake shop and pantry next door.
According to an Instagram post, ownership envisions “this new space as a place where you can pick up a slice of cake, a bottle of wine or a loaf of bread on the way home from work — or the perfect pit stop for your kiddos on their walk home from school to snag that much-needed afternoon pick-me-up.”
The shop is open Friday-Sunday, 11 a.m.-6 p.m. Custom cake orders will soon be available.
To learn more, visit avl.mx/bfo.
Atheists of WNC hosts a Festivus celebration on Tuesday. Dec. 23, 5:30-7:30 p.m., at the Pack Memorial
Library auditorium. Inspired by Frank Costanza’s anti-consumerist holiday celebration on the NBC sitcom “Seinfeld,” the gathering seeks to foster community through fun activities.
Pizza, water and soda will be provided. Attendees are welcome to bring other sharable food and beverages, though alcohol is not permitted. According to the event description, there will also be an optional gift exchange, for which interested parties are invited “to wrap and bring one or more funny/strange things that you want ‘out of the house.’”
Free to attend, but RSVPs are requested to help with planning for refreshments.
To learn more, visit avl.mx/xmasjbw.
Asheville-based caterer Red Fiddle Vittles is taking orders for its 2025 Christmas preorder menu. The takehome offerings feature ingredients from local farmers and foragers that the chef team canned, confited or preserved during the summer, including tomatoes, pawpaws, muscadines, tomatoes, mushrooms and blackberries.
“During the height of the summer, we set aside the best of what our partner farmers and foragers had to offer, knowing that we would feature them at the end of the year,” says Erica Beneke, owner and executive chef, in a press release. “These flavors remind us that even in the coldest months, there’s a promise that warmer, sunnier days will return.”
Among the Christmas dinner dishes are honey-glazed roast duck from Joyce Farms, a cauliflower gratin with melted leeks, plus a selection of appetizers and desserts, including eggnog bread pudding with brandy caramel sauce. Gluten-free, vegetarian and vegan options are available. Pickup is Wednesday, Dec. 24. 10 a.m.-4 p.m. To learn more, visit avl.mx/f8f.

Multiple local restaurants are offering special New Year’s Eve dining options to close out 2025.
• Posana’s downtown and Biltmore Park restaurants will offer a festive four-course prix fixe menu for $125 per person, with optional wine pairings available for $50. A children’s menu is also available for $45. Prices exclude tax, beverages and gratuity. Seatings are available 5-10 p.m. To learn more, visit avl.mx/f8g.
• Bargello at Kimpton Hotel Arras offers seatings 5-9 p.m. for a fourcourse prix-fixe menu featuring flavors of the Mediterranean coastline. The cost is $125 per person with an optional wine pairing for $75. Tax and gratuity are not included. To learn more, visit avl.mx/f8h.
• Upping the ante, Jargon has a fivecourse supper for $150 per person that includes a Champagne toast for each table. Vegan and gluten-free options are available as well as optional wine pairings. Seatings are 5-9:45 p.m. Alcohol, gratuity and tax are not included, and the restaurant’s regular menu will not be available. To learn more, visit avl.mx/f8i.
• And to close out the night, Capella on 9 hosts a New Year’s Eve party, 8 p.m.-12:30 a.m. Tickets are $100 per person and include one drink, food stations and passed hors d’oeuvres, a Champagne toast to ring in 2026 and unlimited photos at the TapSnap photo booth. Music will be provided by DJ Phantom Pantone in the Rave Room and Pure Indigo at the main bar. Dress is upscale casual. To learn more, visit avl.mx/f8j — Edwin Arnaudin X





by Edwin Arnaudin
Spending New Year’s Eve watching live music is a tried and true way to close out December. But standup comedy offers its own brand of entertainment and cathartic release that’s just as potent in its own way. Harnessing that power, the Wicked Weed Funkatorium hosts Caleb Synan on Wednesday, Dec. 31, at 7 p.m. A native of Franklin County, Ga., this preacher’s kid is now based in Los Angeles and has performed on TBS ’ “Conan” twice, once on NBC’s “Last Comic Standing” and had his first Comedy Central special, “30,” premiere in 2022. The evening also features an opening set from actor and comedian Jenny Jennings.
Tickets are $20 in advance, $25 the day of the show and $28 for premium seating, which guarantees table seating in the first three rows. Best (?)

of all, the event will finish by 9 p.m., leaving plenty of time for the latenight shenanigans of your choosing.
To learn more, visit avl.mx/f8m. X

Once the Christmas rush begins to subside, it’s time to make your way outside and rejoin society. The Junior Appalachian Musicians of Henderson County (JAM Kids) make that reintegration easier with a fundraiser on Saturday, Dec. 27, at 6 p.m. at Trailside Brewing Co., in Hendersonville.
The event features performances by Grammy-winning singer-songwriter Jim Lauderdale — who was also recently inducted into the Nashville Songwriter’s Hall of Fame — and Henderson County native Aaron
Burdett, a fellow award-winning songwriter and the lead singer of Ashevillearea legends Steep Canyon Rangers. But kicking off the night are the JAM Kids themselves, who’ll play some traditional old-time and bluegrass music they’ve learned in the after-school program alongside local artist and JAM Kids Executive Director Carol Rifkin. Tickets are $20-$100, and all proceeds support the program through its parent nonprofit, the French Broad Valley Music Association.
To learn more, visit avl.mx/cw2. X
Cornerstones of the local Americana scene, Amanda Anne Platt & The Honeycutters continue to grow their already stellar reputation with each new album and performance. And the next opportunity to catch them live promises to be especially worthwhile.
Back at The Grey Eagle on Saturday, Dec. 20, the band presents Holiday Spectacular V, the latest chapter in its annual yuletide tradition. The show will feature originals and holiday classics, celebrating the season with the group’s distinct blend of humor and heartache. A few special guests will also join them onstage to make the night even more special.
Further specifics are under wraps, though Platt tells Xpress that she’s “looking forward to a sweet hometown show with lots of holiday cheer.” Tickets are $30.25, and the show starts at 8 p.m.
To learn more, visit avl.mx/f8l. X


According to its mission statement, local nonprofit Uplift, Renew, and Sustain the Arts (URSA) Asheville was founded in 2025 by pianist/educator Bill Bares “to provide transformative musical experiences” that adhere to its titular goals.
On Tuesday, Dec. 23, at the Wortham Center for the Performing Arts, the organization holds its inaugural concert featuring its flagship ensemble, the Constellations Orchestra, composed of top musicians from the Asheville area. Under Bares’ direction, the performances will feature one set re-creating
the sounds of the original A Charlie Brown Christmas album with help from drummer Mike Clark, who performed on composer Vince Guaraldi’s original Peanuts TV specials’ soundtracks in the 1970s. The second set will showcase three new interpretations and arrangements of the classic holiday material, commissioned by local composers. The shows take place at 3 and 7 p.m. Tickets are $30-$75 for adults and $20 for students and children ages 12 and younger. All proceeds support URSA Asheville.
To learn more, visit avl.mx/f8k. X




For questions about free listings, call 828-251-1333, opt. 4.
EDA'S HIDE-A-WAY
WEDNESDAY, DECEMBER 17
12 BONES BREWING
SMOKEHOUSE & BREWING
Trivia Night w/King Trivia, 7pm
CORK & KEG BAR
K.C. Jones & Daniel Coolik (jazz), 8pm
FLEETWOOD’S PSK Karaoke, 9pm
FRENCH BROAD
RIVER BREWERY
Saylor Brothers Jamgrass Wednesdays, 6:30pm
GALACTIC PIZZA Trivia Night, 6:30pm
HI-WIRE BREWINGBILTMORE VILLAGE Weekly Trivia, 7pm
HIGHLAND BREWING CO.
Well-Crafted Music Series: Phil Barker w/ Evan Martin and Zach Smith (multi-genre), 6pm
JACK OF THE WOOD PUB
Old-time Jam, 5pm
OKLAWAHA
BREWING CO.
Wednesday Bluegrass Jam w/Finklestein
Three, 6:30pm
PISGAH BREWING CO.
Bear Bones (Grateful Dead tribute), 6pm
SHAKEY'S
SSIN w/DJ Ragga Massive, 10pm
SLY GROG LOUNGE
Weird Wednesday (electro-pop), 8pm
STATIC AGE RECORDS
Silver Kyrie, Angeloclast & Jacob FM (folk) , 8pm
SWEETEN CREEK
BREWING Witty Wednesday Trivia w/Ellie, 6:30pm
THE GREY EAGLE
Dillon Fence (alt-rock, pop-rock), 8pm
THE ODD
Terraoke Karaoke Takeover, 9pm
THE ONE STOP AT ASHEVILLE MUSIC
HALL
Strictly Liquid (funk, jazz, rock), 9pm
TURGUA BREWING CO.
Lightning Round Trivia w/ Marty, 6pm
TWIN LEAF BREWERY
Open Mic Night, 6:30pm
VOWL BAR AT DSSOLVR
Group Therapy w/ Neptune Spins, 9pm
THURSDAY, DECEMBER 18
185 KING STREET
The Pisgah Jazztet (jazz), 7pm
CROW & QUILL Lock, Stock & Teardrops (country) 8pm
Bless Your Heart Trivia w/Harmon, 7pm
FITZ AND THE WOLFE
Prime Country w/ Braelyn (country), 5pm
FLEETWOOD’S
Dauber, Kreamy L'tric Santa & Tiny Tvs (punk), 9pm
FLOOD GALLERY
True Home Open Mic, 6pm
FRENCH BROAD RIVER BREWERY
Jerry's Dead Thursdays, 6pm
GREEN MAN BREWING Thursday Night Trivia, 7pm
HI-WIRE BREWINGBILTMORE VILLAGE Family Feud Style Trivia, 7pm
HI-WIRE SOUTH SLOPE
South Slope’s Open Mic Night, 6pm
JACK OF THE WOOD PUB
Bluegrass Jam, 7pm
OKLAWAHA BREWING CO.
• Kid Billy (funk, soul, Americana), 7pm
• Thursday Karaoke, 9:30pm
ONE WORLD BREWING WEST
Fee Fi PHaux Fish, 8pm
ONE WORLD BREWING
Nathan Robinson (acoustic), 7pm
PILLAR ROOFTOP BAR
Harry Potter Trivia, 6:30pm
PISGAH BREWING CO.
Clouds of Delusion (Grateful Dead tribute), 7pm
SHAKEY'S Karaoke w/DJ Franco Nino, 9pm
STATIC AGE LOFT
Auto-tune Karaoke w/ Who Gave This B*tch a Mic, 10pm
STATIC AGE RECORDS
Decide Today, Dylan Metz & Corpse Dust (Industrial), 8pm
TAPROOM AT HIGHLAND BREWING CO.
Clock Out, Rock Out: Dance Party for Early Birds, 6pm
THE JOINT NEXT
DOOR
Roots & Dore (Americana, blues), 7pm
THE ONE STOP AT ASHEVILLE MUSIC
HALL
Justin Stanton (electronic), 10pm
THE ORANGE PEEL
Thievery Corporation w/ City Of The Sun (alt-rock, edm, jazz), 8pm
THE TIKI EASY BAR
Holiday Trivia, 7pm
TWIN LEAF BREWERY Trivia Night, 6:30pm
URBAN ORCHARD
CIDER CO. Wayward Trivia, 6:30pm

NEW
On Wednesday, Dec. 31, DJ Lil
will be counting down the minutes till the new year with a dance party at Eulogy, starting at 9 p.m. The last party of the year also features a drag performance from Josie & the Pu$$ycats. Photo courtesy of DJ Lil Meow Meow
VOWL BAR AT DSSOLVR
Hot Couch Karaoke w/ DJ BridalPartiBucardi, 8pm
FRIDAY, DECEMBER 19
185 KING STREET
Fireside Collective (rock), 8pm
CORK & KEG BAR
Brody Hunt & The Silent Knights (country), 8pm
EDA'S HIDE-A-WAY
Dylan Earl w/ Christopher Seymore (country), 8pm
ELEVATED
KAVA LOUNGE
DOWNTOWN
Open Mic Night, 8pm
EULOGY
Jon Stickley Trio (bluegrass, rock), 7pm
FITZ AND THE WOLFE
• 80s Night w/Carolina Tumbleweed, 7pm
• The Cool Yule Club: Alex Eubanks Honky Tonk Holiday Show, 9pm
FLEETWOOD’S
We Have Ignition, Harriers of Discord & Paprika (indie), 9pm
FRENCH BROAD
RIVER BREWERY
The Miller Sisters, 6pm
GINGER'S REVENGE
Revenge Cult Trivia: Holiday Movies, 7pm
LOBSTER TRAP
Dinah's Daydream (Gypsy, jazz), 6:30pm
MAD CO. BREW
HOUSE Andrew Wakefield (bluegrass), 6pm
MILLS RIVER BREWING CO.
The Jon Cox Band (country), 6:30pm
NIGHTSHADE
Raíz y Ritmo w/DJ
Malintzin & Brandon Manitoba, 10pm
OKLAWAHA BREWING CO.
Kayla McKinney Band (country), 8pm
ONE WORLD
BREWING WEST
Beat The Holiday Blues w/ Mama (blues, rock), 9pm
ONE WORLD BREWING
• Mojo Mountain Duo (blues, country), 7pm
• Thievery Corporation
After Party w/Reflective Habitat, 11pm
PISGAH BREWING CO.
Phuncle Sam (Grateful Dead tribute), 8pm
PRITCHARD PARK
DOWNTOWN
The Friday Drum Circle, 6pm
SHAKEY'S 2000s Karaoke w/DJ Franco Nino, 10pm
SOVEREIGN KAVA
Vinyl Night (multigenre), 8pm
STATIC AGE RECORDS
Halogi, VRAS & Graven
Lore (metal, punk), 9pm
TAPROOM AT HIGHLAND BREWING CO.
Kuf Knotz & Christine
Elise (hip hop, soul), 7pm
THE CROW & QUILL
Black Sea Beat Society (Balkan, folk), 8pm
THE JOINT NEXT DOOR
Rick Hornyak & The Highway Companions (Americana, rock), 7pm THE ODD
Blankstate, Motocrossed, Dish & Porcelain Parrot (Emo, indie, pop), 9pm THE ONE STOP AT ASHEVILLE MUSIC HALL
• Daws Boss (country, folk, indie), 6pm
• Funkgettaboutit (funk), 10pm
THIRD ROOM
SoDown w/ AYCH (edm, funk), 9pm
VOWL BAR AT DSSOLVR
Booty & Bass w/ DJ BruHaus, YAHZAY& DJ Savvy G, 9pm
SATURDAY, DECEMBER 20
185 KING STREET
Fireside Collective (rock), 8pm
ASHEVILLE CITY HALL
9th Annual Very Jerry Xmas w/Spiro (Grateful Dead, Jerry Garcia, tribute), 9pm
BURGER BAR
The Best Worst Karaoke in Asheville, 8pm
CORK & KEG BAR
Zydeco Ya Ya Rocks, 8pm
CROW & QUILL
Meschiya Lake & The Moodswingers (jazz), 8:30pm
EDA'S HIDE-A-WAY
John Howie Jr & The Rosewood Bluff & Hearts Gone South (country), 8pm
EULOGY
Floating Action w/ Coconut Cake (indiepop), 8pm
FITZ AND THE WOLFE
• Jim McGuinn Band (country), 7pm
• The Cool Yule Club: Drayton’s Jazz Holiday Show, 9pm
FRENCH BROAD RIVER BREWERY Clouds of Delusion (Grateful Dead tribute), 6pm
GREEN MAN BREWING The Z-Man Experience (rock, Ska), 3pm
JACK OF THE WOOD PUB
• Nobody’s Darling String Band (bluegrass, blues, swing), 4pm
• The Asheville Mountain Boys (bluegrass), 8:30pm
MILLS RIVER BREWING CO.
• Iggy Radio, 2pm
• Kristen Toole Band (country), 6:30pm
NIGHTSHADE Psychedelic Nights Before Xmas w/Medisin, Kri, & Purrriestess (psydub), 9pm
OKLAWAHA BREWING CO.
Felonious Monks (funk), 7pm
ONE WORLD BREWING WEST
Hilliary’s Holiday Spectacular (comedy), 7pm
ONE WORLD BREWING
Holly Jolly Roger: A Very Pirate Christmas w/Acklen Walker (multigenre), 8pm
PISGAH BREWING CO.
Sauce Bros (Members of Suns of Stars) (bluegrass), 2pm
SHAKEY'S
Trash Talk Queer Dance Party & Drag Show, 10pm
SHILOH & GAINES
Leeda Lyric Jones (funk, jazz, soul), 9pm
SOVEREIGN KAVA
DJ Uncle Rizz, 8pm
STATIC AGE RECORDS
Scribblers, Jake
Toedtman & Supaheat (power-pop), 8pm
TAPROOM AT HIGHLAND BREWING
CO.
Kid Billy (blues, indiefolk, jazz), 6pm
THE CROW & QUILL
Meschiya Lake & The Moodswingers (jazz), 8pm
THE GREY EAGLE
Amanda Anne Platt & The Honeycutters Holiday Spectacular (folk, Americana), 8pm
THE MULE
• A Very Reggie, Bob & Blue Twilight Christmas (funk, soul), 3pm
• Miss Vee’s Freakshow Presents: Honk For a Cause, 8pm
THE ODD Party Foul Drag, 8pm
THE ONE STOP AT ASHEVILLE MUSIC
HALL
Riyen Roots (blues, roots, soul), 6pm
THIRD ROOM
Granola Funk Express w/ Dub Kartel & Sounding Arrow + RickiiRain (funk, hip-hop), 8pm
SUNDAY, DECEMBER 21
185 KING STREET
Open Electric Jam w/ The King Street House Band, 5pm
27 CLUB
Bryan Bielanski (rock'n'roll), 7pm
BURIAL SOUTH SLOPE Mourning Mass, 2pm
DSSOLVR
Freshen Up Open Mic Comedy, 7pm
EDA'S HIDE-A-WAY
Open Mic Night, 6pm
FRENCH BROAD RIVER BREWERY
Reggae Sunday w/ Chalwa (reggae), 3pm
GINGER'S REVENGE
Jazz Jam Sundays, 2:30pm
JACK OF THE WOOD PUB
• Bluegrass Brunch w/ The Bluegrass Brunch Boys, 12pm
• Traditional Irish Music Session, 3:30pm
ONE WORLD BREWING WEST
• Suns of Stars Sunday Residency (bluegrass), 2pm
• One Love Sundays w/ Strong Fire (reggae, Ska), 7pm
PISGAH BREWING CO.
Sunday Jam: Spiro & Friends, 6:30pm
RIVER ARTS DISTRICT BREWING CO.
RAD Cellar Comedy, 7pm
TAPROOM AT HIGHLAND BREWING
CO.
Detective Blind (alt-rock), 2pm
THE GREY EAGLE
Datrian Johnson & The Family Tree’s Annual Soulful Christmas (soul), 7pm
THE MULE
The 40, 20, 10’s (Americana), 3pm
THE ONE STOP AT ASHEVILLE MUSIC
HALL
Shakedown Sundays, 8pm
THIRD ROOM
Tribal-Tronics w/ Kalimba Man & Chinobay (electronic), 7pm
WELL PLAYED BOARD GAME CAFÉ
Sunday Morning Trivia Brunch, 10:30am
MONDAY, DECEMBER 22
27 CLUB
Rock Star Karaoke w/ Grimm Morrison, 9pm
DIATRIBE BREWING Big Brain Trivia, 7pm

DIRTY JACK'S
Traditional Old Time Jam, 5:30pm
FLEETWOOD’S
Best Ever KaraokeKaraoke, 8pm
FRENCH BROAD RIVER BREWERY
Alex Bazemore & Friends (multi-genre), 6pm
HI-WIRE RAD BEER GARDEN
RAD Music Bingo, 7pm
ONE WORLD BREWING WEST
Mashup Mondays (funk, jazz, soul), 8pm
ONE WORLD BREWING Open Mic Downtown, 7:30pm
RIVER ARTS DISTRICT BREWING CO. Trivia w/Billy, 7pm
STATIC AGE LOFT The Hot Seat w/C.J. Green & Cam (comedy), 7pm
TAPROOM AT HIGHLAND BREWING CO.
Trivia Night W/Two Bald Guys & A Mic, 6pm
THE JOINT NEXT DOOR
Mr. Jimmy & Friends (blues), 7pm
TUESDAY, DECEMBER 23
185 KING STREET
Tuesday Family Jam w/ Jon Stickley & Mike Guggino (blues, country, funk), 6:30pm
ARCHETYPE BREWING Trivia Tuesdays, 6:30pm BURGER BAR
C U Next Tuesday Trivia, 9pm
DIATRIBE BREWING Irish Session, 4pm
ELUVIUM BREWING Not Rocket Science Trivia, 6pm
FRENCH BROAD RIVER
BREWERY
Robert’s Totally Rad Trivia, 7pm
HI-WIRE RAD BEER
GARDEN
RAD Weekly Trivia, 7pm
HI-WIRE SOUTH SLOPE
Trivia Tuesdays w/ Not Rocket Science, 7pm
MILLS RIVER BREWING CO.
Tuesday Night Trivia, 6pm
OKLAWAHA BREWING CO.
• Team Trivia, 7pm
• Karaoke, 9:30pm
ONE WORLD BREWING WEST
Tuesday Residency w/ Songs from the Road Band (Americana, bluegrass, folk), 7pm
SHAKEY'S Booty Tuesday in The Office, 10pm
SHILOH & GAINES
Music Bingo, 7pm
SOVEREIGN KAVA Open Jam, 8pm
SWEETEN CREEK BREWING
All Arts Open Mic, 6pm
TAPROOM AT HIGHLAND BREWING CO.
Music Bingo w/Spencer, 6pm
THE JOINT NEXT DOOR
Moonbeatz (country, folk, rock), 6pm
THE ONE STOP AT ASHEVILLE MUSIC HALL
• Early Tuesday Jam, 7pm
• Uncle Lenny's Krazy Karaoke, 10pm
THIRD ROOM Open Decks, 8pm
TURGUA BREWING CO.
Django Jazz Jam w/ Fatty (jazz), 5:30pm
WHITE HORSE BLACK MOUNTAIN Nothin’ But the Blues Jam, 7:30pm
WEDNESDAY, DECEMBER 24
12 BONES BREWING SMOKEHOUSE & BREWING Trivia Night w/King Trivia, 7pm
FRENCH BROAD RIVER BREWERY
Saylor Brothers Jamgrass Wednesdays, 6:30pm
GALACTIC PIZZA
Trivia Night, 6:30pm
HI-WIRE BREWINGBILTMORE VILLAGE Weekly Trivia, 7pm
JACK OF THE WOOD PUB
Old-time Jam, 5pm
OKLAWAHA BREWING CO. Wednesday Bluegrass Jam w/Finklestein Three, 6:30pm
SHAKEY'S SSIN w/DJ Ragga Massive, 10pm
SLY GROG LOUNGE
Weird Wednesday (electro-pop), 8pm
SWEETEN CREEK BREWING Witty Wednesday Trivia w/Ellie, 6:30pm THE ODD Terraoke Karaoke Takeover, 9pm
TURGUA BREWING CO.
Lightning Round Trivia w/ Marty, 6pm
TWIN LEAF BREWERY Open Mic Night, 6:30pm
THURSDAY, DECEMBER 25
EDA'S HIDE-A-WAY
Bless Your Heart Trivia w/Harmon, 7pm
FLOOD GALLERY
True Home Open Mic, 6pm
GREEN MAN BREWING Thursday Night Trivia, 7pm
HI-WIRE BREWINGBILTMORE VILLAGE
Family Feud Style Trivia, 7pm
HI-WIRE SOUTH SLOPE
South Slope’s Open Mic Night, 6pm
OKLAWAHA BREWING CO. Thursday Karaoke, 9:30pm
ONE WORLD BREWING WEST Fee Fi PHaux Fish, 8pm
SHAKEY'S Karaoke w/DJ Franco Nino, 9pm
TWIN LEAF BREWERY Trivia Night, 6:30pm
URBAN ORCHARD
CIDER CO.
Wayward Trivia, 6:30pm
VOWL BAR AT DSSOLVR
Hot Couch Karaoke w/ DJ BridalPartiBucardi, 8pm
FRIDAY, DECEMBER 26
185 KING STREET
Carolina Tumbleweed (Americana, blues, country, funk), 8pm
ASHEVILLE MUSIC
HALL
Cosmic Charlie (Grateful Dead tribute), 9pm
ELEVATED KAVA
LOUNGE DOWNTOWN
Open Mic Night, 8pm
FITZ AND THE WOLFE
Virginia & the Slims (jazz), 8pm
FLEETWOOD’S
Good Vicious: Indie DJ Night, 10pm
FRENCH BROAD RIVER
BREWERY
Jerry's Dead Thursdays, 6pm
JACK OF THE WOOD
PUB
Lenny Pettinelli & Friends (rock, soul), 8:30pm
LOBSTER TRAP
Dinah's Daydream (Gypsy, jazz), 6:30pm
MAD BREW CO.
The Candleers (country), 6pm
OKLAWAHA BREWING CO.
Crystal Fountains (multigenre), 7pm
PRITCHARD PARK
DOWNTOWN
The Friday Drum Circle, 6pm
SHAKEY'S 2000s Karaoke w/DJ Franco Nino, 10pm
SIERRA NEVADA
BREWING CO.
Eric Congdon & The Estradas (rock), 3pm
THE CROW & QUILL Firecracker Jazz Band (jazz), 8:30pm
THE GREY EAGLE
Tell Me Lies (Fleetwood Mac tribute), 8pm



THE JOINT NEXT DOOR
Soul Blue Rocks (blues, R&B, soul), 8am
THE MEADOW AT HIGHLAND BREWING
CO. Ross Hollow (indie-folk), 7pm
THE ONE STOP AT ASHEVILLE MUSIC HALL
Daws Boss (country, folk, indie), 6pm
THE PALM ROOM AT FITZ AND THE WOLFE
The Cool Yule Club:
Chris Vita's Classic Country Christmas Carolin', 10:30pm
WHITE HORSE BLACK MOUNTAIN
Unwrap the Funk
w/Anne Combs & Company Funk (funk), 7:30pm
SATURDAY, DECEMBER 27
185 KING STREET
New Dawn Starkestra (Americana, blues, country), 6pm
ASHEVILLE MUSIC HALL
Rhizome Music Showcase feat 5AM
Trio, Dredlok, Maxfield, Murkury & Notlo (edm), 9pm
BURGER BAR
The Best Worst Karaoke, 8pm
CROW & QUILL
Meschiya Lake & The Moodswingers (jazz), 8:30pm
EDA'S HIDE-A-WAY
The Old Chevrolette Set (country), 8pm
EULOGY
• Necrogasm, Razorgrave & Old Dead Gods (death-metal), 7pm
• FOMO Frequencies, 10:30pm
FITZ AND THE WOLFE
• Prime Country Band (country), 7pm
• The Cool Yule Club: The Swingin’ Poppies Groovy Jazz Lounge, 10pm
FLEETWOOD’S
Bad Fidelty, Blistering
Dissonance, In Dog Years & Rhine Jive Clique (punk), 8:30pm
FRENCH BROAD RIVER BREWERY
Abby Bryant & Natalie Brooke (jazz), 8pm
GREEN MAN BREWING
The Z-Man Experience (rock, Ska), 3pm
JACK OF THE WOOD PUB
• Nobody’s Darling String Band (bluegrass, blues, swing), 4pm
• The JackTown Ramblers (bluegrass, gypsy jazz), 8:30pm
OKLAWAHA BREWING
CO.
Abbey Elmore Band (indie-pop), 8pm
ONE WORLD
BREWING WEST
The Miller Sisters (folk, indie), 7pm
ONE WORLD
BREWING
Hannah Ramsey (blues, folk, jazz), 7pm
PISGAH BREWING CO. Chalwa Roots (reggae), 4pm
SHILOH & GAINES
Candler Rice Holiday Party (country, folk), 8pm
SIERRA NEVADA BREWING CO.
Aubrey Eisenman & The Clydes (Americana, folk), 2pm
SOVEREIGN KAVA
Mike Rhodes Fellowship (funk), 9pm
STATIC AGE LOFT
Time Lapse (house), 8pm
TAPROOM AT HIGHLAND BREWING
CO.
Queen Bee and the Honeylovers (blues, Latin, swing), 6pm
THE CROW & QUILL
Meschiya Lake & The Moodswingers (jazz), 8pm
THE GREY EAGLE
The Cheeksters w/ Doss Church & the Unholy Noise (indie), 8pm
THE ODD Party Foul Drag, 8pm
THE ONE STOP AT ASHEVILLE MUSIC
HALL
Riyen Roots (blues, roots, soul), 6pm
THE ORANGE PEEL Nirvani (Nirvana tribute) 8pm
SUNDAY, DECEMBER 28
185 KING STREET
Open Electric Jam ft. the King Street House Band, 5pm
BURIAL SOUTH SLOPE
Mourning Mass, 2pm
CORK & KEG BAR
Milonga Del Barrio (Argentine-tango), 3pm
DSSOLVR
Freshen Up Open Mic Comedy, 7pm
EDA'S HIDE-A-WAY
Open Mic Night, 6pm
FRENCH BROAD
RIVER BREWERY
Reggae Sunday w/ Chalwa (reggae), 3pm
GINGER'S REVENGE
Jazz Jam Sundays, 2:30pm
JACK OF THE WOOD PUB
• Bluegrass Brunch w/ The Bluegrass Brunch Boys, 12pm
• Traditional Irish Music Session, 3:30pm
ONE WORLD
BREWING WEST
• Suns of Stars Sunday Residency (bluegrass), 2pm
• One Love Sundays (reggae), 7pm
PISGAH BREWING CO.
Sunday Jam: Spiro & Friends, 6:30pm
RIVER ARTS DISTRICT BREWING CO.
RAD Cellar Comedy, 7pm
THE GREY EAGLE
Women To The Front & Friends: Year End Blues Bash (blues, funk), 7pm
THE MULE
Dungeons & Drafts, 1pm
THE ONE STOP AT ASHEVILLE MUSIC HALL
Shakedown Sundays, 8pm
THE ORANGE PEEL
Mersiv w/Hairitage & Fryar (edm, bass), 7pm
WELL PLAYED BOARD GAME CAFÉ
Sunday Morning Trivia Brunch, 10:30am
MONDAY, DECEMBER 29
27 CLUB
Rock Star Karaoke w/ Grimm Morrison, 9pm
DIATRIBE BREWING Big Brain Trivia, 7pm
DIRTY JACK'S
Traditional Old Time Jam, 5:30pm
FRENCH BROAD RIVER BREWERY
Alex Bazemore & Friends (multi-genre), 6pm
HI-WIRE RAD BEER GARDEN
RAD Music Bingo, 7pm
ONE WORLD
BREWING WEST
Mashup Mondays (funk, jazz, soul), 8pm
ONE WORLD
BREWING
Open Mic Downtown, 7:30pm
RIVER ARTS DISTRICT
BREWING CO.
Trivia w/Billy, 7pm
STATIC AGE LOFT
The Hot Seat w/C.J. Green & Cam (comedy), 7pm
TAPROOM AT HIGHLAND BREWING CO. Trivia Night W/Two Bald Guys & A Mic, 6pm
THE JOINT NEXT DOOR
Mr. Jimmy & Friends (blues), 7pm
TUESDAY, DECEMBER 30
185 KING STREET
Clint Roberts & Friends (Americana, blues, country), 6:30pm
ARCHETYPE BREWING Trivia Tuesdays, 6:30pm
BURGER BAR C U Next Tuesday Trivia, 9pm
DIATRIBE BREWING Irish Session, 4pm
ELUVIUM BREWING
Not Rocket Science Trivia, 6pm
FRENCH BROAD RIVER BREWERY
Robert’s Totally Rad Trivia, 7pm
HI-WIRE RAD BEER GARDEN
RAD Weekly Trivia, 7pm
HI-WIRE SOUTH SLOPE Trivia Tuesdays w/ Not Rocket Science, 7pm
MILLS RIVER BREWING CO.
Tuesday Night Trivia, 6pm
OKLAWAHA BREWING CO.
• Team Trivia, 7pm
• Karaoke, 9:30pm
ONE WORLD
BREWING WEST
Tuesday Residency w/ Songs From The Road Band (Americana, bluegrass, folk), 7pm
SHAKEY'S Booty Tuesday in The Office, 10pm
SHILOH & GAINES
Music Bingo, 7pm
SOVEREIGN KAVA Open Jam, 8pm
SWEETEN CREEK BREWING
All Arts Open Mic, 6pm
TAPROOM AT HIGHLAND BREWING CO.
Music Bingo w/Spencer, 6pm
THE JOINT NEXT DOOR
The Brue (blues, pop, rock), 6pm
THE ONE STOP AT
ASHEVILLE MUSIC
HALL
• The Infamous Stringdusters w/Bronwyn Keith-Hynes (Americana, bluegrass), 8pm
• Uncle Lenny’s Krazy Karaoke, 10pm
THIRD ROOM Open Decks, 8pm
WAGBAR Trivia Tuesdays, 6pm
WHITE HORSE BLACK
MOUNTAIN
Nothin’ But the Blues Jam, 7:30pm
WEDNESDAY, DECEMBER 31
185 KING STREET
Retro Glam NYE w/ Empire Strikes Brass & Huck Pearl (jazz, r&b), 8pm
12 BONES BREWING
SMOKEHOUSE & BREWING
Trivia Night w/King Trivia, 7pm
ASHEVILLE MUSIC
HALL
Sneezy w/Future Joy NYE Party (funk, soul), 9pm
EULOGY
Drag Me To 2026 w/DJ Lil Meow Meow, 8pm
FRENCH BROAD RIVER
BREWERY
Saylor Brothers Jamgrass Wednesdays, 6:30pm
GALACTIC PIZZA Trivia Night, 6:30pm
HI-WIRE BREWINGBILTMORE VILLAGE Weekly Trivia, 7pm
JACK OF THE WOOD PUB
• Old-time Jam, 5pm
• Rae & The Ragdolls NYE Show (folk, psychedelic, rock), 9pm
LEVELLER BREWING CO.
NYE Old Time Jam, 8pm OKLAWAHA BREWING CO.
• Wednesday Bluegrass Jam w/Finklestein Three, 6:30pm
• NYE w/Billingsley (Rock & Roll), 9:30pm
ONE WORLD
BREWING WEST
Reelin’ In The Years: NYE Yacht Rock Dance Party (rock), 9pm
REVIVAL
Good Vicious: Midnight Masquerade NYE Party, 8pm
SHAKEY'S SSIN w/DJ Ragga Massive, 10pm
SLY GROG LOUNGE
Weird Wednesday (electro-pop), 8pm
SOVEREIGN KAVA
New Year's Eve Party w/Lactones, Goodgoat, Gruntwerk, 7pm
SWEETEN CREEK BREWING Witty Wednesday Trivia w/Ellie, 6:30pm
THE CROW & QUILL
• NYE w/Firecracker Jazz Band (Party Jazz), 8pm
THE GREY EAGLE New Year’s Eve w/ Electro Lust (electronic, funk), 8pm
THE JOINT NEXT DOOR
Lefty Carmean & Friends (Americana, folk), 7pm THE ODD Terraoke Karaoke Takeover, 9pm
THE ONE STOP AT ASHEVILLE MUSIC HALL
Carson Moore (jazz fusion), 10pm
THE ORANGE PEEL RJD2 (hip-hop, indie rock), 9pm
TURGUA BREWING CO.
Lightning Round Trivia w/ Marty, 6pm
TWIN LEAF BREWERY Open Mic Night, 6:30pm
VOWL BAR AT DSSOLVR Group Therapy w/ Neptune Spins, 9pm WHITE HORSE BLACK MOUNTAIN
3WB Rock-On New Years Eve (blues, funk, rock), 7:30pm
THURSDAY, JANUARY 1
185 KING STREET Unpaid Bill & the Bad Czechs (folk, ragtime), 7pm
EDA'S HIDE-A-WAY Bless Your Heart Trivia w/Harmon, 7pm FLOOD GALLERY True Home Open Mic, 6pm
FRENCH BROAD RIVER BREWERY Jerry's Dead Thursdays, 6pm
GREEN MAN BREWING Thursday Night Trivia, 7pm
HI-WIRE BREWINGBILTMORE VILLAGE Family Feud Style Trivia, 7pm
HI-WIRE SOUTH SLOPE South Slope’s Open Mic Night, 6pm
JACK OF THE WOOD PUB Bluegrass Jam, 7pm OKLAWAHA BREWING CO.
Thursday Karaoke, 9:30pm
PISGAH BREWING CO.
2026 Hangover Party w/ Phuncle Sam & Mountain View BBQ (psych), 3pm
SHAKEY'S Karaoke w/DJ Franco Nino, 9pm
STATIC AGE LOFT Auto-tune Karaoke w/ Who Gave This B*tch a Mic, 10pm
TWIN LEAF BREWERY Trivia Night, 6:30pm
URBAN ORCHARD CIDER CO. Wayward Trivia, 6:30pm
VOWL BAR AT
DSSOLVR Hot Couch Karaoke w/ DJ BridalPartiBucardi, 8pm

ARIES (March 21-April 19): Nine hundred years ago, Sufi philosopher Al-Ghazali provided rigorous advice that’s not very popular these days. "To understand the stars," he said, "one must polish the mirror of the soul." Here's my interpretation: To fathom the truth about reality, you must be a strong character who treasures clarity and integrity. It's highly unlikely you can gather a profound grasp of how life works if your inner depths are a mess. Conversely, your capacity to comprehend the Great Mystery increases as you work on purifying and strengthening your character. Everything I just said is good advice for all of us all the time, but it will be especially potent and poignant for you in the coming months.
TAURUS (April 20-May 20): The sound of a whip cracking is a small sonic boom. The tip breaks the sound barrier, creating that distinctive snap. In my astrological reckoning, Taurus, life has provided you with the equivalent of a whip. During the coming months, you will have access to a simple asset that can create breakthrough force when wielded with precision and good timing. I’m not referring to aggression or violence. Your secret superpower will be understanding how to use small treasures that can generate disproportionate impacts. What's your whip?
GEMINI (May 21-June 20): Some Japanese potters practice *yohen tenmoku*. It's a technique used to create a rare type of tea bowl with shifting, star-like iridescence on deep, dark glaze. The sublime effect results from a process that's unusually demanding, highly unpredictable, and hard to control. Legend says that only one in a thousand bowls achieves the intended iridescence. The rest, according to the masters, are “lessons in humility.” I believe you can flourish by adopting this experimental mindset in the coming months. Treat your creative experiments as offerings to the unknown, as sources of wonder whether or not your efforts yield stellar results. Be bold in trying new techniques and gentle in self-judgment. Delight in your apprenticeship to mystery. Some apparent “failures” may bring useful novelty.
CANCER (June 21-July 22): A fair-weather cumulus cloud typically weighs over a million pounds and yet floats effortlessly. Let’s make that one of your prime power symbols for 2026, Cancerian. It signifies that you will harbor an immense emotional cargo that’s suspended with grace. You will carry complex truths, layered desires, and lyrical ambitions, but you will manage it all with aplomb and even delight. For best results, don’t overdramatize the heaviness; appreciate and marvel at the buoyancy.
LEO (July 23-Aug. 22): Every 11 years, the Sun reverses its magnetic polarity. North becomes south, and south becomes north. The last switch was completed earlier this year. Let’s use this natural phenomenon as your metaphorical omen for the coming months, Leo. Imagine that a kind of magnetic reversal will transpire in your psyche. Your inner poles will flip position. As the intriguing process unfolds, you may be surprised at how many new ideas and feelings come rumbling into your imagination. Rather than resist the cosmic acrobatics, I advise you to welcome and collaborate with them.
VIRGO (Aug. 23-Sept. 22): The sculptor Louise Bourgeois was asked why she worked so often with the image of the spider. She said it was a tribute to her mother, who was deliberate, clever, patient, soothing, helpful, and useful—just like a spider. In the coming months, I invite you to embody her vision of the spider. You will have the wherewithal to weave hardy networks that could support you for years to come. Be creative and thoughtful as you craft your network of care. Your precision will be a form of devotion. Every strand, even fragile ones, will enhance your long-term resilience.
BREZSNY
feel "wrong" or create tension—is in part culturally determined. Indonesia’s gamelan music and Arabic maqam scales are beautiful to audiences that have learned to appreciate them. But they might seem off-kilter to Westerners accustomed to music filled with major thirds and triads. Let’s use this as our starting point as we contemplate your future in 2026, Libra. Life may disrupt your assumptions about what constitutes balance and harmony. You will be invited to consider the possibility that what seems like discord from one perspective is attractive and valuable from another. My advice: Open your mind to other ways of evaluating what’s meaningful and attractive.
SCORPIO (Oct. 23-Nov. 21): In the Sonoran Desert of the southwestern United States, Arizona bark scorpions are hard to see at night. Scientists who want to study them can find them only by searching with flashlights that emit ultraviolet light. This causes the scorpions’ exoskeletons to fluoresce and glow a distinct blue-green or turquoise color, making them highly visible. Let’s use this scenario as a metaphor for you. In the coming months, you may reveal your best brilliance under uncommon conditions. Circumstances that seem unusual or challenging will highlight your true beauty and power. What feels extreme may be a good teacher and helper. I urge you to trust that the right people will recognize your unique beauty.
SAGITTARIUS (Nov. 22-Dec. 21): According to legend, the genius composer Mozart heard entire symphonies in his imagination before he wrote down any notes. That’s a slight exaggeration. The full truth is that he often worked hard and made revisions. His inspiration was enhanced by effort and craft. However, it’s also true that Mozart wrote at least five masterful works in rapid succession, sometimes with remarkably few corrections on the manuscript. They included his last three symphonies (Nos. 39, 40, and 41). I predict you will have a Mozart-like aptitude in the coming months: the ability to perceive whole patterns before the pieces align. Trust your big visions!
CAPRICORN (Dec. 22-Jan. 19): In Greek mythology, Proteus was a sea god famed for his ability to change his shape endlessly to evade capture. But now and then, a persistent hero was able to hold on to Proteus through all his transformations, whether he became a lion, serpent, tree, or flame. Then the god would bestow the gift of prophecy on the successful daredevil. I suspect that in the coming months, you will have an exceptional power to snag and grasp Proteus-like things, Capricorn. As a result, you could claim help and revelations that seem almost magical.
AQUARIUS (Jan. 20-Feb. 18): In Florence, Italy, the Accademia Gallery houses several of Michelangelo's sculptures that depict human figures partially emerging from rough blocks of marble. They seem to be caught in the process of birth or liberation. These works showcase the technique Michelangelo called *non-finito* (unfinished), in which the forms appear to struggle to escape from the stone. In the coming months, Aquarius, I foresee you undergoing a passage that initially resembles these figures. The good news is that unlike Michelangelo's eternally trapped characters, you will eventually break free.
PISCES (Feb. 19-March 20): To prepare you for 2026, I’ve gathered three quotes that address your most pressing need and urgent mandate. I recommend you tape this horoscope to your bathroom mirror. 1. “We cannot live in a world interpreted for us by others. An interpreted world is not a hope. Part of the terror is to take back our listening, to use our own voice, to see our own light.” —author Elaine Bellezza. 2. “To be yourself in a world that is constantly trying to make you something else is the greatest accomplishment.” — Ralph Waldo Emerson. 3. “The ability to tell your own story, in words or images, is already a victory, already a revolt.” —Rebecca Solnit.
Want to advertise in Marketplace? 828-251-1333 advertise@mountainx.com • mountainx.com/classifieds
REAL ESTATE SERVICES
WESLEY FINANCIAL GROUP, LLC TIMESHARE CANCELLATION EXPERTS
Over $50,000,000 in timeshare debt and fees canceled in 2019. Get free informational package and learn how to get rid of your timeshare! Free consultations. Over 450 positive reviews. Call 844-2136711. (NC Press)
2 BEDROOM 1 BATH APARTMENT In Black Mountain. $995 per month. With new laminate hardwood floors. Heating and cooling. Washer dryer connections. Great neighborhood! 828-252-4334
2 BEDROOM 2 BATH MOBILE Accepting Section 8. $1495 per month. New laminate hardwood floors. West AVL. 2-3 miles from town. On the bus line.Very quiet neighborhood. 828-252-4334
APARTMENT MAINTENANCE HELP NEEDED $25 per hour. Full time.
Experience preferred. Electrical and plumbing. The Woods Townhomes. 165 Coleman Ave, 28801. Call Steve on 828-273-9545 or email wncinvestmentgroup@ yahoo.com

SALES ASSOCIATE Work for a local company that has covered the local scene for 30 years! Mountain Xpress newspaper is a supportive, team-oriented environment serving local readers and businesses. We are seeking an experienced and enthusiastic advertising sales representative. Ideal candidates are personable, organized, motivated, and can present our company with confidence. Necessary skills include clear and professional communications (via phone, email, and in-person meetings), detailed record-keeping, and self motivation. Experience dealing with varied and challenging situations is helpful. The position’s responsibilities include account development and lead generation (including cold-calling), account management, assisting clients with marketing and branding strategies. If you are a high energy, positive, cooperative person looking to join an independent media organization, please send a resume and cover letter (no walk-ins, please) explaining why you are a good fit for Mountain Xpress to: xpressjob@mountainx.com.


This is a noncommissioned position. There is potential for a performance-based annual bonus.
GET A HIGH QUALITY, MODERN DESIGN BATH or shower transformation in as little as One Day. $0 Down, $0 Installation, $0 Payments for 12 months! Call: 1-877243-7050. (NC Press)
BEHIND ON YOUR MORTGAGE PAYMENTS? Threatened with foreclosure? Denied a loan modification? Let us help! Call the Homeowner Relief Line to speak with a mortgage specialist 844-492-0883 (NC Press)
CONNECT TO THE BEST WIRELESS home internet with earthling. Enjoy speeds from 5G and 4G LTE networks, no contracts, easy installation, and data plans up to 300 GB. Call 855-873-2215 (AAN CAN)
DENIED SOCIAL SECURITY DISABILITY? APPEAL! If you're 50+, filed SSD and denied, our attorneys can help. Win or Pay Nothing! Strong, recent work history needed. 877-553-0252 [Steppacher Law Offices LLC Principal Office: 224 Adams Ave Scranton PA 18503] (NC Press)
DENTAL INSURANCE from Physicians Mutual Insurance Company. Coverage for 400 plus procedures. Real dental insurance - NOT just a discount plan. Get your FREE Dental Information Kit with all the details! 1-866-4305905 (AAN CAN)
DIRECTV All your entertainment. Nothing on your roof! Sign up for Directv and get your first three months of Max, Paramount+, Showtime, Starz, MGM+ and Cinemax included. Choice package $84.99/mo. Some restrictions apply. Call DIRECTV 1-855-606-4520 (AAN CAN)
GET A BREAK ON YOUR TAXES! Donate your car, truck, or SUV to assist the blind and visually impaired. Arrange a swift, no-cost vehicle pickup and secure a generous tax credit for 2025. Call Heritage for the Blind today at 1-855-869-7055 today! (NC Press)
GET DISH SATELLITE TV + INTERNET! Free install, free HD-DVR upgrade, 80,000 on-demand movies, plus limited time up to $600 in gift cards. Call today! 1-877920-7405. (NC Press)
GOT AN UNWANTED CAR? Donate it to Patriotic Hearts. Fast free pick up. All 50 states. Patriotic Hearts’ programs help veterans find work or start their own business. Call 24/7: 1-833426-0086. (AAN CAN) HOME BREAK-INS Take less than 60 seconds. Don't wait! Protect your family,
An Evening with Jan Richardson


First Baptist Church of Asheville • 5 Oak St. Wednesday, Dec. 17 • 5:30pm A conversation with this author/creator of breathtaking words and art who will draw us into solstice imagination and wonder.



your home, your assets now for as little as 70¢ a day! Call 1-833-881-2713
(AAN CAN)
MOBILEHELP America's premier mobile medical alert system. Whether you're home or away. For safety and peace of mind. No long term contracts! Free brochure! Call today! 1-877-667-4685
(AAN CAN)
NEED NEW WINDOWS?
Drafty rooms? Chipped or damaged frames? Need outside noise reduction? New, energy efficient windows may be the answer! Call for a consultation & FREE quote today. 1-833-890-1293
(AAN CAN)
PEST CONTROL Protect your home from pests safely and affordably. Roaches, Bed Bugs, Rodent, Termite, Spiders and other pests. Locally owned and affordable. Call for service or an inspection today! 1-833-406-6971
(AAN CAN)
PREPARE FOR POWER
OUTAGES TODAY With a Generac Home Standby Generator. Act now to receive a FREE 5-year warranty with qualifying purchase. Call 1-866-3810627 today to schedule a free quote. It’s not just a generator. It’s a power move. (AAN CAN)
REPLACE YOUR ROOF With the best looking and longest lasting material – steel from
Erie Metal Roofs! Three styles and multiple colors available. Guaranteed to last a lifetime! Limited time offer – up to 50% off installation + additional 10% off install (for military, health workers & 1st responders). Call Erie Metal Roofs: 1-855-585-1815. (NC Press)
STOP OVERPAYING FOR AUTO INSURANCE A recent survey says that most Americans are overpaying for their car insurance. Let us show you how much you can save. Call now for a no obligation quote: 1-833-399-1539 (AAN CAN)
WATER DAMAGE CLEANUP & RESTORATION A small amount of water can lead to major damage and mold growth in your home. We do complete repairs to protect your family and your home's value! For a free estimate, call 24/7: 1-833-880-7762 (AAN CAN)
WATER DAMAGE CLEANUP & RESTORATION A small amount of water can lead to major damage in your home. Our trusted professionals do complete repairs to protect your family and your home's value! Call 24/7: 1-833-9281861. Have zip code of service location ready when you call! (NC Press)
WE BUY HOUSES for Cash AS-IS! No repairs. No fuss. Any condition. Easy process: Call, get cash offer and get



paid. Call today for your fair cash offer: 1-877-939-1331 (AAN CAN)
WE BUY HOUSES FOR CASH AS IS! No repairs. No fuss. Any condition. Easy three step process: Call, get cash offer and get paid. Call today for your fair cash offer: 1-919-925-6362 (NC Press)
WE BUY VINTAGE GUITARS Looking for 1920-1980 Gibson, Martin, Fender, Gretsch, Epiphone, Guild, Mosrite, Rickenbacker, Prairie State, D'Angelico, Stromberg. And Gibson Mandolins / Banjos. These brands only! Call for a quote: 1-833-641-6624 (AAN CAN)
WE BUY VINTAGE GUITARS! Looking for 1920-1980 Gibson, Martin, Fender, Gretsch, Epiphone, Guild, Mosrite, Rickenbacker, Prairie State, D'Angelico, Stromberg. And Gibson Mandolins / Banjos. These brands only! Call for a quote: 1-833-641-6577. (NC Press)
WESLEY FINANCIAL GROUP, LLC TIMESHARE CANCELLATION EXPERTS
Over $50,000,000 in timeshare debt and fees canceled in 2019. Get free informational package and learn how to get rid of your timeshare! Free consultations. Over 450 positive reviews. Call 888-960-1781 (AAN CAN)
NO MORE CLEANING OUT GUTTERS. GUARANTEED! LeafFilter is the most advanced gutter protection for your home, backed by a no-clog guarantee and lifetime transferable warranty. Call today 1-877-649-1190 to schedule a FREE inspection and no obligation estimate. Plus get 20% off! Seniors and military save an additional 10%. Restrictions apply, see representative for warranty and offer details. (NC Press)
PUBLIC SALE OF VEHICLE
To satisfy a lien for a 2006 Ford F-150 against Bridging Communityes Inc for $8,045.00; 2015 Toyota Camry against Matthew Brian Hicks for $7,765.00; 2015 Ford Mustang against Damian Jimenez Mendoza for $7925.00; 2017 Chevy Equinox against Jonathan Lynn Dowdy and Regional Acceptance Corp for $7245. Auto Safe Towing Inc., 474 ½ N. Louisiana Ave., Asheville NC 28806. 828-2361131 Publication: December 10, 2025 Publisher: Mountain Xpress


1 Protection from an infection
5 Movie theater popcorn container
8 Kurt who fronted Nirvana
14 Accusative, for one
15 Muff or fluff
16 “Be that as it may …”
17 Image depicted in this puzzle by connecting the circled letters alphabetically
20 Aristophanes comedy, with “The”
21 Sailors’ patron
22 Energize
24 King George ___, “Hamilton” character
25 Some H.S. teams
28 Remote batteries
30 Social ___
32 Condiment sometimes known as rooster sauce
37 It keeps you in the dark
38 “Is it too risky?”
39 Brand whose customers made its Super Bowl ad in 2025
41 Appetites
42 Sporty convertible
44 Like some ironed shirts and fall air
45 Free pass in sports
46 “The Spanish Tragedy” playwright Thomas
47 Washboard parts
49 Grocery aisle enticement
55 Beer brand discontinued in 2010
58 Wading bird
59 Image in this puzzle
63 Steve of “Battle of the Sexes”
64 “Tubular!”
65 With a clean slate
66 What some people think this puzzle’s image represents
67 U.K. home
68 Eliot of the Untouchables
DOWN
1 Say “As if!,” e.g.
2 Clamdigger pants style
3 First American multimillionaire
4 Sand-colored
5 Beverage sometimes served with cucumber sandwiches
6 Web addresses
7 Like the words “knackered” and “chuffed”
8 Bowed instruments
9 Haploid cell
10 Kiss, in Córdoba
11 Unlucky “Wheel of Fortune” purchase for COOL AS A CUCUMBER
12 Prefix with -metric
13 French resistance?
18 Fort Collins sch.
19 Hawaiian souvenir
Website with a “Conservadox”
27 Co. that merged with Neiman’s in 2024
Great service provider 30 Late-night host Seth 31 Put out 32 “Excuse me” 33 Stiff 34 Bad time for Caesar
Hoarse voice
“Let’s call it ___”
What some people think this puzzle’s image represents
Many Pablo Neruda works
No-name
One paying for a full-price ticket, perhaps
Poke bowl fish
Soccer great Rapinoe 52 Wrinkly fruit 53 Pixelated, informally 54 Cable show covering the red carpet
55 Nickname of the “Love Yourself” singer, with “the” 56 Wrinkly fruit
57 Isaac’s favorite son 59 Counterpart of down: Abbr.
